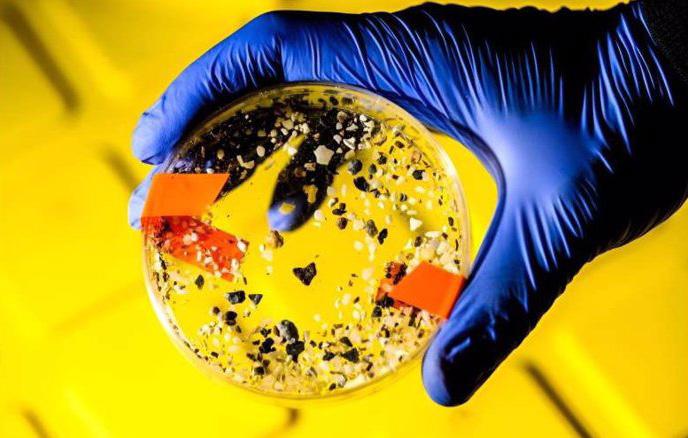

Convocada por la Diócesis de Cuernavaca, el objetivo es enviar un mensaje a las autoridades de los tres niveles del gobierno para que actúen y rescaten a Morelos de los grupos del crimen organizado que han tomado el control de la entidad. PAG 5
Ante la alta demanda de electricidad y la poca generación de energía, el organismo anuncia que tomará las decisiones pertinentes, por lo que existe riesgo de más apagones
Incapacidad. El riesgo a que se registren más apagones en el país por la ola de calor que propicia el incremento en la demanda del servicio de electricidad sigue latente, lo que obligó este sábado al Centro Nacional de Control de Energía (Cenace) declarar en alerta al estado operativo del Sistema Interconectado Nacional. A través de un comunicado, el Cenace reportó una primera declaratoria de alerta a las 05:43 horas de la mañana y una segunda a las 08:23 horas de este sábado, en el que subraya que se aplica el Estado Operativo de Alerta en el Sistema Interconectado Nacional, por
lo que llevará a cabo las acciones operativas conducentes para el control de la distribución y suministro de electricidad, por lo que podrían ocurrir algunos cortes de energía. El Cenace refiere que se prevé que el punto más alto de la demanda eléctrica este sábado ocurra a partir de las 21:00 horas. La declaratoria de Alerta permitiría tomar la decisión de interrumpir el servicio eléctrico en distintas regiones del país como consecuencia de la alta demanda energética y a que hay una reducción en la capacidad de generación de electricidad. PAG 4
HERENCIA
Jorge Aguilar - Página 10
Detienen con droga al Kevin “N”, hijo de “El Ojos”, exlíder del Cártel de Tláhuac

UNANIMIDAD Página 17
El Papa abraza como hermanos a un palestino y a un israelí

Último debate; presidenciables van por último jalón para convencer a indecisos
Jaloneo. El último jalón de la campaña electoral por la Presidencia de la República entró en su clímax, donde los candidatos, Claudia Sheinbaum, abanderada de la 4T; Xóchitl Gálvez, por la alianza PAN-PRI-PRD y Jorge Álvarez Máynez, por Movimiento Ciudadano, apuestan por sacar lo mejor de sus propuestas de gobierno para convencer a los in-
Activan nuevamente fase 1 de contingencia ambiental para el Valle de México
decisos que aún evalúan la mejor propuesta en temas de Violencia y crimen organizado; Migración y política exterior; Democracia, pluralismo y división de poderes. Aunque las encuestas favorecen a Sheinbaum, el voto de quienes aún no deciden por quién votarán el próximo 2 de junio podría ampliar la ventaja o acercar la sorpresa para Xóchitl. PAG 6
Los siervos oyen y obedecen
Turbulencia. La Comisión Ambiental de la Megalópolis (CAMe) informó que se activa la Fase I de contingencia ambiental por ozono en la Zona Metropolitana del Valle de México, a causa de concentraciones máximas de ozono de 160 y 157 ppb. La entrada a la contingencia coincide con la “marcha de la democracia”, en la que miles de personas vestidas de rosa, se darán cita en el Zócalo capitalino. PAG 10
Para no agotar las reservas frente al incremento en la demanda del servicio, el Centro Nacional de Control de Energía recurrirá nuevamente al corte de electricidad regional, medida que refleja la falta de previsión habida hace años. Habrá que ver si estamos acumulando ahora mismo más apagones para el futuro.
En la inconmensurable labor de don Rafael Cansinos Assens de traducir íntegro el compendio hasta ahora conocido de “Las mil y una noches”, con las versiones de Mardrus, Burton, Weill y otros, hay una expresión frecuente: escucho y obedezco.
La dicen los siervos a sus amos; los esclavos y esclavas a sus dueños.
Obviamente en ese maravilloso libro de libros, en el cual, se guarda toda la sabiduría arábiga o muy buena parte de ella con sus aventuras fantásticas, sus batallas, sus guerras, sus reyes vivos y muertos; los amores, las pasiones bisexuales, las lujuriosas, y hasta los fantasmas y vampiros de la mitología, no se podría haber cifrado la obsecuencia de quien presidiera algo parecido al Instituto Nacional Electoral. No había de eso.
Era otro mundo.
Pero el género humano no ha cambiado mucho. La obediencia frente al poderoso ya sea emir, sultán, califa; rey o presidente, es la misma. Y la re -
SUBE Y BAJA
Xabi Alonso DT del Bayer Leverkusen

El estratega español del equipo alemán se llevó todos los honores al ser ovacionado por afición y directivos del conjunto alemán, al que convirtió en el primer campeón invicto de la Bundesliga, con 28 triunfos y 6 empates.
Sergio Checo Pérez Piloto de F1

El mexicano tuvo una pésima jornada en la clasificación del Gran Premio de Emilia Romaña (Italia), donde erró en la estrategia, lo que lo deja hasta el sitio 11 de la arrancada, lejos de aspirar al podio, en una pista que se le complica.
LA
compensa del sometimiento, también.
Oigo y obedezco, dijo —por ejemplo—, doña Guadalupe Taddei quien seguramente ha leído las casi 5 mil páginas de esta obra clásica de la cultura islámica, en la cual abundan las expresiones de rigor coránico:
“Cuando al hombre Alá priva
De entendimiento,
Es vano cuanto haga
Pues sordo y ciego
No atina de su daño
Con el remedio…”
Estos versos equivalen, de alguna manera a decir:
“Si Natura non lo da, Salamanca non lo presta”, lo cual es cierto. Y si además no has ido a Salamanca --ni de turista--, pues peor.
En todo esto puede uno reflexionar mientras mira el azul del cielo (desde mi ventana de ayer por la tarde el cielo del sur era azur) y confirma como la inútil CAME, emite contingencias ambientales cuando hay marchas de los opositores. Perdón, de los traidores a
la patria.
Rafael Cardona Twitter:@CardonaRafael por complacerte…”
Y también coinciden con la queja eterna de la izquierda quejumbrosa, porque el señor Mario Delgado, presidente de Morena, chilló porque los opositores convocaron a una marcha con ropajes porque ese es el color del logotipo del INE.
Y eso les parece subliminalmente un mensaje de ¿qué?, quien sabe, pero quieren confiscar hasta la paleta del Pantone.
“Aunque el #PRIAN se vista de rosa, #PRIAN se queda”. ¡Ay tú!
Y si bien Mario se enreda al hablar de una supuesta marcha cuando lo único supositivo (no supositorio, eso es otra cosa) es la naturaleza ciudadana de su origen, según él.
Pero Mario habla y la señora Taddei, oye y obedece. No podría ser de otra manera pues su parcialidad es una evidencia bastante gorda, porque a ella le queda en parte este fragmento de la historia de Hassan (Noche 448) a quien las mujeres de la historia le decían:
“…En tus manos estamos y cualquier cosa que nos pidieres luego la haremos

SANTO EN EL MUSEO
Inauguran la Primera Feria de los Museos del Centro Histórico en la Plaza Tolsá y el Palacio de Minería de la UNAM. En la foto, una figura de cera del legendario luchador El Santo. (Foto: Ddgar Negrete- Cuartoscuro.com)

Las órdenes del califa se acatan así el oído solo perciba las palabras del mensajero Martino.
—(AP).- Sin mencionar directamente a la “Marea Rosa”, Guadalupe Taddei, presidenta del Instituto Nacional Electoral (INE), hizo un llamado a la sociedad civil para que deje de utilizar este color que ha caracterizado al organismo por muchos años.
“La petición de la consejera presidenta surge un día después de que la coalición de Morena, PVEM y el PT solicitara al Consejo General del INE dejar de usar el color rosa para que “la identidad institucional no se confunda” con la de la coalición del PRI, PAN y PRD, así como de la imagen de la candidata Xóchitl Gálvez”.
El rosa, y ella lo sabe, se usa desde el fallido intento de mantener sin manoseos al INE. Por eso es rosa.
Perro aun cuando no lo encontré ni en la obra ya dicha ni en el Corán, uno oye a la Taddei y sólo puede decir:
“¡Ah, chingao!, salió re obediente la señora…” •

Oscar Wilde sale de prisión
El 19 de mayo de 1897, en Reino Unido, Oscar Wilde sale de la cárcel de Reading, donde había sido confinado por homosexual.
1921. En Estados Unidos se promulga la primera Ley de Cuotas, que restringe la inmigración.
1962 . Marilyn Monroe le canta Happy Birthday Mr. President al entonces mandatario John F. Kennedy.
1974. Erno Rubik crea el famoso cubo de Rubik.
2018. En Reino Unido se celebró la boda entre el príncipe Enrique de Sussex y Meghan Markle.

Ante la alta demanda de electricidad y la poca generación de energía, el Centro Nacional de Control de Energía anuncia que tomará las decisiones pertinentes para no agotar la electricidad de reserva
Mario D. Camarillo nacional@cronica.com.mxEl riesgo a que se registren más apagones en el país por causa de las altas temperaturas debido al incremento en la demanda del servicio de electricidad sigue latente, lo que obligo a que desde la primera hora este 18 de mayo, el Centro Nacional de Control de Energía (Cenace) declarara en alerta al estado operativo del Sistema Interconectado Nacional.
A través de un comunicado, el Cenace reportó una primera declaratoria de alerta a las 05:43 horas de la mañana y una segunda a las 08:23 horas de este sábado, en el que subraya que se aplica el Estado Operativo de Alerta en el Sistema Interconectado Nacional, por lo que llevará a cabo las acciones operativas conducentes
para el control de la distribución y suministro de electricidad, por lo que podrían ocurrir algunos cortes de energía.
El Cenace refiere que se prevé que el punto más alto de la demanda eléctrica este sábado ocurra a partir de las 21:00 horas con 46 mil 157 megawatts.
La declaratoria de Alerta, de acuerdo con el Centro Nacional de Control de Energía, permitiría tomar la decisión de interrumpir el servicio eléctrico en distintas regiones del país como consecuencia de la alta demanda energética y a que hay una reducción en la capacidad de generación de electricidad.
Después de tres días consecutivos sin apagones, este sábado el Cenace emitió la declaratoria de alerta, ante el incremento en el consumo de energía que el día viernes fue de 40 mil 138 megawatts, mien-

tras que la generación de electricidad neta fue de 40,179 megawatts.
El estado de alerta se declara para lograr condiciones de confiabilidad y seguridad en la operación. Entre las medidas que se toman, se encuentra la posibilidad de interrumpir el servicio eléctrico.
Los primeros registros de declaratoria de alerta y de emergencia se aplicaron entre el 7 y 11 de mayo pasados, en el mar-
co de la segunda ola de calor que azotó al país y que obligó a miles de personas a utilizar con una alta demanda el servicio eléctrico, por lo que al persistir altas temperaturas el esquema de incremento en el uso de la electricidad ha obligado a las autoridades del Cenace a volver a aplicar el mismo esquema para no agotar todas las reservas que tiene en existencia y que estarían por debajo del 6 por ciento •
A cinco meses para que culmine el sexenio del presidente Andrés Manuel López Obrador, y como parte de la reestructuración periódica que lleva a cabo la Secretaría de Marina Armada de México, la institución informó cambios en la Subsecretaría, con lo que designa como nuevo titular del área a el Almirante Julio César Pescina Ávila, en sustitución del Almirante José Luis Arellano Ruiz.
Pescina Ávila es originario de Veracruz; ingresó a la Heroica Escuela Naval Militar en 1975, obtuvo la Maestría en Defensa y Seguridad Hemisférica en la Universidad de el Salvador, en Argentina, así como, el Curso de Altos Estudios de Defensa y Seguridad Hemisférica, en el Colegio
Interamericano de Defensa, con sede en la Ciudad de Washington, DC. de los EU.
Entre los cargos que ha desempeñado están el haber sido Oficial de cargo, Jefe de Máqui-

nas, segundo Comandante y Comandante. Catedrático-Instructor de la Heroica Escuela Naval Militar, Ayudante Naval del Oficial Mayor de Marina, Jefe de Sección Segunda de Estado Mayor, Jefe de Curso de Estado Mayor en el Centro de Estudio Superiores Navales, Director de Dragado y Desarrollo Portuario de la SEMAR, Jefe de Ayudantes del Oficial Mayor de Marina, Agregado Naval a la Embajada de México en Argentina, concurrente con la República Oriental del Uruguay, Jefe de Estado Mayor de la Séptima Zona Naval y de la Sexta Región Naval, Director General de Investigación y Desarrollo de la Secretaría de Marina, Coordinador del Órgano Interno de Control en la Secretaría de Marina, Rector de la Universidad Naval, Comandante de la Octava Región Naval, Comandante de la Décimo segunda Región Naval, Comandante de la Fuerza Naval del Golfo e
Inspector y Contralor General de Marina.
Se ha hecho merecedor de las Condecoraciones de Perseverancia de Sexta a Primera Clase; así como, de Perseverancia Excepcional de Tercera y Segunda Clase; Mérito Docente Naval Primera Clase; Condecoración Facultativo Naval Primera Clase por haber obtenido el primer lugar en la Maestría y Curso de Estado Mayor en el Centro de Estudios Superiores Navales; Distintivo del Estado Mayor General de la Armada; Medalla de la Armada de Argentina al Mérito; por haber realizado una meritoria labor en el desempeño de sus funciones como Agregado Naval en la Embajada de México en Argentina; otorgada por la República de Argentina; Integrante de la Legión de Honor, por haber demostrado una limpia carrera jerárquica, otorgada por la Secretaria de la Defensa Nacional. (Mario D. Camarillo) •
Manifestación masiva contra la violencia e inseguridad, en la décima “Marcha por la Paz”
Mario D. Camarillo nacional@cronica.com.mx
Unidos en una sola voz, miles de ciudadanos de Morelos e incluso visitantes, se manifestaron este sábado en Cuernavaca en una marea humana en favor de la paz, en contra de la violencia y la inseguridad que han robado la tranquilidad a quienes habitan la entidad.
Convocada por la Diócesis de Cuernavaca, desde la mañana de este 18 de mayo se llevó a cabo la décima “Marcha por la Paz”, donde el objetivo es enviar un mensaje a las autoridades de los tres niveles del gobierno para que actúen ya y rescaten a Morelos y sus habitantes de los grupos del crimen organizado que han tomado el control de la entidad.
“El 30 por ciento (de la violencia) ha aumentado en Morelos en 2024, es una pena, una tristeza y un dolor tan grande que, en vez de disminuir, se aumentó”, subrayó el obispo Ramón Castro Castro, quien convocó a esta mo-

vilización y quien reiteró que la violencia ha aumentado en Morelos en este año y no ha disminuido como aseguran las autoridades estatales y federales. Ramón Castro, quien también es secretario general de la Conferencia del Episcopado Mexicano (CEM), insistió en que “esta violencia (que es cotidiana en Morelos) no creo solamente que tenga tintes políticos. Hunde sus raíces en terrenos más profundos todavía. Sabemos que el crimen organizado está tratando de organizar e influir en las elecciones. Eso todo el mundo lo sabe, está obligando a un sector del pueblo a votar por ciertos partidos”, denunció, al subrayar que es ilógico
Guerrero. PRI condena asesinato de su candidato
La dirigencia nacional del PRI condenó el asesinato del candidato a regidor por el tricolor en el municipio de Coyuca de Benítez, Guerrero, Aníbal Zúñiga Cortés, y de su esposa, Rubí Bravo Solís y exigió a las autoridades que den con los responsables y apliquen todo el peso de la ley.
“Ya basta de que el proceso electoral se empañe con tanta violencia”, expresó el dirigente nacional del PRI, Alejandro Moreno luego de enviar sus condolencias y su solidaridad a sus familiares.
Por separado, el CEN del partido condenó el terrible homicidio de Aníbal Zúñiga Cortés, y de su esposa, Rubí Bravo Solís.
Además de exigir justicia ante el atroz asesinato, la dirigencia nacional del PRI urgió al gobierno federal y al estatal que tomen cartas en el asunto, y les demandó que dejen de actuar como si la violencia y el crimen no se hubieran apoderado ya del proceso electoral. El CEN del tricolor puntualizó que “basta ya de indiferencia”, y estableció que “México exige vivir en paz”.

pensar que las autoridades desconozcan e esta situación.
Derivado de la violencia desenfrenada del pasado fin de semana en el municipio de Huitzilac, al menos 14 escuelas de nivel básico y medio superior decidieron suspender lasclases para resguardar la integridad de la comunidad estudiantil y de los docentes.
Hasta el momento el Gobierno Federal ha hecho promesas de reforzar la seguridad, lo que ha quedado en el discurso, toda vez que el interés prioritario para el gobierno de la 4T es ver el resultado que salga de la elección para la gubernatura del estado el próximo 2 de junio •
En la víspera fueron asesinados dos aspirantes a puestos públicos, uno de ellos fue el candidato a regidor por Coyuca de Benítez, Aníbal Zúñiga Cortes y su esposa Rubí Bravo Solís en Acapulco, y Lucero López Meza, candidata a la alcaldía de La Concordia en Chiapas.
Por la mañana del viernes, se reportó que se localizon 6 cuerpos descuartizados en Acapulco, Guerrero; horas más tarde, el dirigente del PRI en ese estado, Alejandro Bravo Abarca confirmó que se trataba del candidato Aníbal Zúñiga Cortes y su esposa Rubí Bravo Solís.
Por otra parte, en Chiapas Lucero López Meza candidata Lucero López Maza, quien aspiraba a la presidencia municipal de La Concordia en Chiapas por el Partido Popular Chiapaneco fue asesinada en medio de una balacera donde perdieron la vida otras cuatro personas, entre ellas una menor de edad cuando regresaban de un mítin político.
El presidente López Obrador, lamentó la muerte de Lucero López Maza y confirmó que hay 2 grupos del crimen organizado enfrentándose, sin embargo, negó que haya problemas graves de inseguridad en Chiapas. (Alejandro Páez) •
Policías municipales y estatales de Tijuana se han convertido en el blanco de agresiones y asesinatos de grupos criminales que operan en la convulsa Tijuana, en Baja California, lo que ha encendido las alarmas en la Fiscalía del Estado, toda vez que el objetivo de los Cárteles de la droga que operan en la región buscan minar los puntos de seguridad de las fuerzas del orden y eliminar a quienes no han aceptado sobornos o trabajar para ellos.
Tijuana, ciudad clave en la frontera entre México y EU es paso obligado de mercancías y personas, lo que ha convertido también a la región en centro de operaciones de grupos criminales que buscan controlar el mercado de la droga, extorsión, secuestros y tráfico de migrantes.
La Fiscal del estado, María Elena Andrade, reconoció que en los cuatro meses y medio del 2024 se han registrado 12 ataques contra policías, de los cuales cuatro culminaron con la muerte de los uniformados.
VIOLENCIA
La funcionario recordó que tan solo el pasado 15 de mayo, dos policías municipales fueron atacados en dos acciones distintas, mientras que dos más fueron asesinados; el cuerpo de uno de ellos fue abandonado en un lote baldío y el otro mientras se trasladaba en su auto particular, quien se desempeñaba como jefe de la Policía Municipal de la Zona Centro.
“Ahorita sí estamos en una alerta, lo platicamos con el secretario (de seguridad municipal de Tijuana) Fernando Sánchez, por lo que ha acontecido
estos últimos días de agresiones a agentes de la policía municipal de este municipio”, dijo la fiscal general ante medios.
La Fiscal General refirió que las investigaciones aún son “muy preliminares”, pero de entrada descartó que estos asesinatos y agresiones contra los uniformados estén vinculados entre sí, se ñalando que “es un tema atípico”; aunque no descartó investigar el entorno personal de cada uno de los agentes.
“Siempre que hay una agresión a un policía de cualquier corporación la primera investigación se va relacionada en torno a lo personal y lo laboral, me refiero a aseguramientos que hayan tenido recientemente (…) a no ser que haya una evidencia flagrante de que algún policía haya andado en alguna actividad ilícita que haya generado alguno de los ataques”, expresó.
Por su parte, policías municipales de Tijuana y de la sección comercial se manifestaron en las instalaciones del Ayuntamiento para exigir condiciones dignas de trabajo, pues consideran que al realizar un trabajo de alto riesgo al menos deberían tener mejores sueldos, seguro de vida digno y prestaciones •
La Fiscalía del Estado encendió las alarmas por los 12 ataques que se han registrado contra los uniformados en lo que va del año
Claudia, Xóchitl y Jorge discutirán sobre Violencia y crimen organizado; Migración y política exterior; Democracia, pluralismo y división de poderes
Mario D. Camarillo nacional@cronica.com.mx
El último jalón de la campaña electoral por la Presidencia de la República entró en su clímax, donde los candidatos, Claudia Sheinbaum, abanderada de la 4T; Xóchitl Gálvez, por la alianza PAN, PRI y PRD y Jorge Álvarez Máynez, por Movimiento Ciudadano, apuestan por sacar lo mejor de sus propuestas de gobierno para convencer a los indecisos que aún evalúan la mejor propuesta. Los temas a tratar en el tercero y último debate los temas de violencia y crimen organizado; Migración y política exterior; Democracia, pluralismo y división de poderes.
INDECISOS, CLAVE
Aunque las encuestas marcan una ventaja que parece casi definitiva en favor de Sheinbaum, el voto de quienes aún no deciden por quién votarán el próximo 2 de junio podría ampliar la ventaja o acercar la sorpresa para Xóchitl, la candidata que

Finalizan detalles en el set de grabación para el tercer debate presidencial que se realizará este domingo en las instalaciones del Centro Cultural Universitario Tlatelolco.
va segunda en las preferencias y quien aún confía en el milagro del voto ciudadano.
El I nstituto Nacional Electoral ( INE) recordó que el último encuentro entre los tres candidatos presidenciales es este 19 de mayo a las 20:00 horas, en el Centro Cultural Tlatelolco, donde los aspirantes serán cuestionados sobre violencia y crimen organizado; Migración y política exterior; Democracia, pluralismo y división
de poderes.
Aunque para este último ejercicio se espera que queden atrás los ataques y descalificaciones entre Claudia y Xóchitl, todo apunta que la rivalidad y ataques serán una copia de las dos ediciones pasadas, donde los golpes bajos serán nuevamente protagonistas.
De Álvarez Máynez no hay mucho qué decir, ya que buscará aprovechar el debate de descalificaciones de sus adversarias,
para reiterar que él es la mejor opción y donde convocará nuevamente al llamado a la comunidad universitaria para sumarse a su propuesta de gobierno.
De acuerdo con el esquema marcado por el INE para el tercero y último debate, éste comenzará con el segmento 1, donde las candidatas y el candidato harán un planteamiento sobre el primer tema durante un minuto y después responderán a una misma pregunta, con el mismo tiempo.
Para el segmento 2, la s candidaturas responderán la misma pregunta para abrir camino al debate, solo que en esta ocasión tendrán cinco minutos en bolsa de tiempo cada una para intercambiar ideas y este esquema se repetirá en el segmento 3.
El segmento 4 será con preguntas cruzadas que serán leídas por los moderadores y después se abrirá un espacio para respuestas. En este bloque cada candidatura tendrá un minuto para responder y posteriormente tendrán un espacio para réplicas de un minuto cada uno.
Finalmente, al terminar los segmentos, cada participante tendrá un minuto para un último mensaje para la ciudadanía.
El INE espera que predomine la madurez política y queden de lado los ataques y golpes bajos y que las propuestas de gobierno sean las que acaparen los reflectores previo a la elección histórica del 2 de junio, donde si no hay sorpresas, una mujer será la primera presidenta de México •
Con
del
12
conteos rápidos,
la
noche
2 junio
habrá certeza para dar tendencias a la Presidencia: INE
Una vez que concluya la jornada electoral del 2 de junio, la consejera presidenta del Instituto Nacional Electoral (INE), Guadalupe Taddei, saldrá la noche del mismo domingo a informar la tendencia que lleva la votación para la Presidencia de la República.
El INE tiene por primera vez la oportunidad de realizar 12 conteos rápidos de la votación a la que están llamados poco más de 98 millones de mexicanos.
Taddei Zavala destacó como histórico que se tengan 12 Conteos Rápidos para la elección presidencial, de diputaciones federales y senadurías, ocho gubernaturas y la Jefatura de la CDMX.
Acompañada de integrantes del Comité Técnico Asesor de los Conteos Rápidos (Cotecora), estos último manifestaron su confianza en que todo correrá conforme
a lo previsto para dar a conocer, en tiempo y forma los resultados de los Conteos Rápidos sobre las tendencias y estimaciones de la jornada electoral.
HORA INDEFINIDA
La hora del anuncio dependerá, de acuerdo con Patricia Isabel Romero Mares, integrante del Cotacora, de que exista información completa de la “cartografía electoral”, el monitoreo de la muestra, además de que no se presenten sesgos significativos en las estimaciones de los especialistas, cosa que, apuntó, difícilmente ocurrirá, y que no falte información de alguna parte del país.
“El Instituto Nacional Electoral (INE) cuenta con el acompañamiento y la asesoría de los especialistas que integran el Cote-
cora, lo que incrementa la certeza respecto a la información que estos instrumentos arrojarán la misma noche de de las elecciolnes”, enfatizó la consejera presidenta.
Previo a esta certeza, el instituto ha realizado ensayos para asegurar que el sistema de conteos rápidos funciona sin ningún problema.
“Se prueba todo, desde el operativo de campo, donde los Capacitadores Asistentes Electorales tengan la experiencia de trabajar en caso de que les toque una casilla muestra, se prueba todo el sistema del conteo rápido, es decir, la transmisión de la información de los CAE a las Juntas Distritales, y de éstas al sistema de la UTSI”. La información, agregó, llega en forma de remesas cada 5 minutos. Remesas que se van acumulando para que los especialistas vayan haciendo estimaciones cada 10 o 15 minutos, con la finalidad de ver cómo se están comportando las estimaciones”, precisó Romero Mares. (Eloísa Domínguez) •
Cinvestav avala ciberseguridad para el voto electrónico en el extranjero
Expertos en c iberseguridad y criptografía del Centro de de Investigación y de Estudios Avanzados (Cinvestav) avalaron la calidad técnica del Instituto Nacional Electoral (I NE) pa ra recoger el voto electrónico de los mexicanos residentes en el extranjero. El árbitro electoral informó que tras pruebas técnicas aplicadas por los científicos del Cinvestav se verificó el cumplimiento operativo de las reglas establecidas para esta modalidad de voto en la Ley General de Instituciones y Procedimientos Electorales (LGIPE).
Los investigadores en software, ciberseguridad y criptografía, procedentes de tres de Zacatenco, Guadalajara y Tamaulipas, concluyeron la auditoría que se realizó del 16 de febrero al 30 de abril, de acuerdo con un comunicado emitido por el INE.
“La auditoría concluyó que el voto eléctrico en el extranjero permitirá que las mexicanas y los mexicanos residentes en el extranjero participen con (confianza) en los Procesos Electorales Concurrentes 2023-2024, y cumple con los elementos técnicos requeridos en el modelo operativo y la normatividad vigente. El árbitro electoral recordó que esta modalidad será usada para votar en las elecciones de Presidencia y Senadurías y en las elecciones de Jefatura de Gobierno, gubernaturas, diputaciones migrantes y de representación proporcional en el ámbito local, según corresponda en Chiapas, Ciudad de México, Guanajuato, Jalisco, Edomex, Morelos, Oaxaca, Puebla y Yucatán, cuya legislación establece el voto de las mexicanas y los mexicanos residentes en el extranjero. (Eloísa Domínguez) •

CELEBRANDO AL QUIJOTE
En el marco del Día Internacional de los Museos, en el Franz Mayer se la inauguró la exposición “Vuelta al Quijote”, una recopilación de ediciones que Franz Mayer reunió a lo largo de su vida.

Debido al incremento de contagios por hepatitis A y tifoidea habitantes de San Cristóbal de las Casas exigen agua limpia y la salida de una refresquera.
La cifra es superior a los 13,632 cupos que hubo en 2023, cuando se registraron más de 178,404 solicitudes
Redacción nacional@cronica.com.mx
Los exámenes de ingreso a licenciatura en la Universidad Nacional Autónoma de México (UNAM) comenzaron este 18 de mayo y culminan el próximo 2 de junio, con una oferta de 13 mil 669 lugares disponibles, cifra superior a los 13 mil 632 cupos de 2023, año en que se presentaron más de 178 mil 404 solicitudes.
El registro para el proceso de ingreso a la UNAM empezó en enero pasado, por lo que a partir entonces y hasta el 17 de mayo los aspirantes podrán obtener su guía de preparación para el examen de admisión.
“Dentro de la sede de examen no está permitido el uso de telé-
fonos celulares o cualquier otro tipo de dispositivo electrónico”, advierte la UNAM en su convocatoria.
Posteriormente, el 18 de julio, la UNAM dará a conocer los resultados de la prueba, y los que lograron ingresar tendrán que realizar un examen de diagnóstico en el conocimiento del inglés. La inscripción en los planteles de la UNAM será del próximo 29 de julio al 2 de agosto, y el siguiente ciclo escolar comienza el 5 de este último mes.
La UNAM tiene dos formas de ingreso a las licenciaturas; una es por el pase reglamentado, la cual es el derecho que tiene un
Quienes logren aprobar procederán a la inscripción del 29 de julio al 2 de agsto
estudiante por pertenecer a un bachillerato de esa institución como la Escuela Nacional Preparatoria (ENP) o el Colegio de Ciencias y Humanidades (CCH).
El otro modo es por el concurso de selección, el cual consiste en realizar el examen de conocimientos y con base a los aciertos obtenidos, los aspirantes obtienen un lugar para estudiar en la UNAM •

Los resultados serán publicados el próximo 18 de julio.
Impulsa PT reformas a la ley para legalizar el trabajo sexual
El Partido del Trabajo en la Comisión Permanente planteó reformas a la Ley Federal del Trabajo para legalizar el trabajo sexual en México empezando por la definición específica de lo que representa esa actividad para miles de personas. La coordinadora del PT en el Senado, Geovanna Bañuelos recordó que el trabajo sexual es uno de los oficios más antiguos del mundo, y en muchos casos es la única forma de subsistir para hombres, mujeres y personas de la comunidad LGBTTTIQ+, por lo que dijo es necesario distinguir delitos como la trata de personas, turismo sexual, entre otros, de la prostitución.
Dijo que se requiera incorporar un capítulo denominado: “De las Personas Trabajadoras Sexuales” a fin de establecer en la ley la definición de “trabajo sexual”, la diferencia de éste con cualquier tipo de delito contra la sexualidad, y la definición de “trabajador sexual” y “persona usuraria” en la ley. Bañuelos explicó que su propuesta busca que a los trabajadores sexuales se les respeten todos sus derechos establecidos en la Constitución, así como la dignificación de su trabajo; el derecho a la salud, a la educa-
ción sexual y reproductiva.
Así como a no ser obligada a relaciones sexuales sin el uso de métodos anticonceptivos, a no ser violentada física, emocional o sexualmente.
Además, establece el deber de las autoridades a respetar y no estigmatizar a las personas dedicadas al trabajo sexual y su derecho a una defensa legal garantizada y proporcionada por el Estado en caso de necesitarla.
Geovanna Bañuelos señaló que actualmente la realidad a la que se enfrentan las personas trabajadoras sexuales está llena de matices, se enfrentan a un contexto de discriminación social y laboral que se caracteriza por los prejuicios, la pobreza y la falta de oportunidades en el mercado de empleo formal, entre otros aspectos.
En este sentido, la líder parlamentaria enfatizó que es necesario crear políticas y programas institucionales para garantizar condiciones dignas de trabajo a quienes ejercen esta profesión.
La iniciativa fue turnada a las comisiones unidas de Trabajo y Previsión Social; y de Estudios Legislativos, Segunda para su análisis y posterior dictaminación. (Alejandro Páez) •

La Unidad Xochimilco de la UAM albergó el Festival Alimentación sustentable; Las abejas también hacen milpa, con intercambio de conocimientos, experiencias y formas innovadoras para fortalecer economías locales
Medio Amiente
Cecilia Higuera Albarrán nacional@cronica.com.mx
Delia Patricia Couturier Bañuelos, coordinadora de la Red de Investigación para el Fortalecimiento de la Economía Social y Solidaria de la Universidad Autónoma Metropolitana (UAM), plantel Xochimilco, destacó la importancia del papel que desempeñan los productores de alimentos en los momentos de constantes desafíos económicos, sociales y medioambientales.
La especialista subrayó que esta comunidad de productores son quienes
con dedicación, creatividad e innovación “nos proveen de alimentos y bienes de primera calidad, son un vínculo tangible con la tierra y con nuestras raíces culturales. Lo mismo las organizaciones sociales que con su compromiso y empatía trabajan incansablemente para abordar las necesidades más apremiantes de nuestra sociedad, desde la educación y la salud hasta el medio ambiente y los derechos humanos”.
Couturier Bañuelos señaló lo anterior, en el marco del inicio en la Unidad Xochimilco, del Festival de Alimentación Sustentable L as abejas también hacen milpa, el cual se llevará a cabo en octubre próximo, cuya finalidad es la de celebrar “la diversidad y la riqueza de nuestros productos agrícolas y servicios, con lo cual se busca además, sentar las
bases para construir relaciones sólidas y colaborativas que permitan enfrentar los desafíos del mañana con mayor resiliencia y determinación.
La investigadora del Departamento de Producción Económica invitó a la comunidad universitaria a aprovechar al máximo esta oportunidad para establecer conexiones significativas, compartir conocimientos y experiencias y explorar formas innovadoras de colaboración que permitan fortalecer las economías locales, promover prácticas sostenibles y construir redes de apoyo mutuo que trasciendan fronteras y diferencias.
“Al unir nuestras fuerzas y nuestros recursos, podemos marcar la diferencia y crear un futuro más humano, equitativo y sostenible para las generaciones venideras”, precisó.
En su oportunidad, al inaugurar la feria en el marco del Día Mundial de la Abeja, el doctor Jaime Ortega Reyna, responsable técnico del Proyecto Alimentación universitaria y sustentabilidad De la milpa a la mesa del Consejo Nacional de Humanidades, Ciencias y Tecnologías (Conahcyt), reconoció a la Coordinación de Gestión Ambiental de la UAM Xochimilco por ocuparse de la difusión de las abejas.
LA IMPORTANCIA DE LAS ABEJAS
Recordó que sin abejas no hay milpa y sin milpas no hay cultura y sin cultura no hay civilización, es decir, que prácticamente la base de todo son estos pequeños insectos “dando la posibilidad de vida” frente a un panorama de riesgo en el que se continúa construyendo grandes complejos sin prever el lugar para el resto de las formas de vida.
En el panel Pr ivatización corporativa de las semillas, neoliberalismos y luchas por la soberanía alimentaria desde el maíz, la doctora Alma Piñeiro Nelson indicó que se han empezado a implementar estrategias de bioseguridad comunitaria para tratar de hacer un diagnóstico biológico, social y económico.
Como en Tabasco, donde se tiene presencia de transgenes en maíces nativos, cuyo planteamiento es que más allá de mejorar la legislación nacional e internacional, también “tenemos que pensar en las estrategias de abajo para arriba, es decir lo que pueden hacer las comunidades ante la presencia de transgenes en sus acervos”.
La investigadora del Departamento de Producción Agrícola y Animal alertó que esta presencia de transgenes en maíces nativos puede tener implicaciones legales, porque las construcciones recombinantes de estas quimeras genéticas que se hacen en laboratorio pueden abrir una demanda por infracción de patente.
“En la Ley de Bioseguridad de nuestro país no queda claro de quién sería la responsabilidad legal si se encuentran estos transgenes entre el agricultor, productor o gobierno, en tanto que el pacto comercial con Estados Unidos y Canadá obliga a México a cambiarse al Convenio UPOV 91”.
La doctora Yolanda Massieu Trigo, docente de la Maestría en Sociedades Sustentables, enfatizó que cada vez más empresas trasnacionales son dueñas de lo que comemos en mayor volumen, sin

importar nuestra salud ni los ecosistemas de nuestro maíz.

“Observamos con preocupación cómo gringos a f uerza quieren vendernos maíz transgénico, atentando así contra una decisión nacional de alimentación, porque en el T-MEC (Tratado comercial entre México, Estados Unidos y Canadá) siempre hemos sido el socio débil; sin embargo, se han valorizado los maíces nativos, lo cual ha permeado más en la sociedad y ahora nos toca defender nuestra soberanía alimentaria”.
La docente en la Licenciatura en So -

ciología y el posgrado Desarrollo Rural refirió que “hay una crisis alimentaria brutal, dado los precios altos de los comestibles a nivel mundial derivados del cambio climático y las guerras”.
Asimismo, la doctora Leticia López Zepeda, directora ejecutiva de la Asociación Nacional de Empresas Comercializadoras de Productores del Campo, puntualizó que el país es autosuficiente en maíz para la nutrición, “producimos el suficiente maíz que nos comemos, con 27 millones de toneladas y para
consumo humano se destinan entre 20 y 21 millones de toneladas, gracias a la resistencia, persistencia de comunidades campesinas que se mantienen defendiendo la tierra”. En nuestro país, donde un connacional promedio consume hasta medio kilogramo de maíz al día, hay 5 millones de productores, de ellos el 70 por ciento tiene menos de cinco hectáreas (ha), mientras que 20 por ciento posee hasta 20 ha, a diferencia de Estados Unidos, ahí uno sólo puede ser dueño de superficies de hasta 800 hectáreas.


Este domingo no circulan los vehículos de uso particular con holograma de verificación 2, 00 y 0, engomado rojo, terminación de placa 3 y 4
Jorge Aguilar metropoli@cronica.com.mx
La Comisión Ambiental de la Megalópolis (CAMe) informó que se activa la Fase I de contingencia ambiental por ozono en la Zona Metropolitana del Valle de México, a causa de que a las 14:00 horas, se registraron concentraciones máximas de ozono de 160 y 157 ppb en las estaciones de Centro de Ciencias de la Atmósfera (CCA), y UAM Xochimilco (UAX), ubicadas en las alcaldías de Coyoacán y Xochimilco respectivamente.
La entrada a la contingencia coincide con la “marcha de la democracia”, en la cual, duran-
te la mañana del domingo, miles de personas vestidas de rosa, se darán cita en el Zócalo capitalino, con la finalidad de exigir elecciones transparentes, honestas y que las instituciones democráticas se respeten.
Aunque es convocada por la ciudadanía, a ella acudirán varios representantes de la oposición, como Santiago Taboada. Hacia ello, los políticos morenistas han lanzado severas críticas, pues aunque dicen que respetan cualquier manifestación, denostan a todos los que tienen afinidad por el PAN - PRI o PRD. Además, existe la presencia de un sistema de alta presión en el centro del país, asociado con una masa de aire con bajo contenido de humedad; la estabilidad atmosférica es fuerte, lo cual ha motivado el estancamiento de los contaminantes precursores del ozono y la formación del mismo, dado que el cielo se ha mantenido despejado, el viento débil, la radiación solar intensa y se han registrado temperaturas mayores a 30 grados.
Mañana domingo 19 de mayo deberán suspender su circulación, en horario de las 5:00 a las 22:00 horas:
Los vehículos de uso particular con holograma de verificación 2.
Los vehículos de uso particular con holograma de verificación 1, cuyo último dígito numérico sea 1, 3, 5, 7 y 9.
Los vehículos de uso particular con holograma de verificación 00 y 0, engomado rojo, terminación de placa 3 y 4.
Las unidades que no porten holograma de verificación, como los vehículos antiguos, de demostración o traslado, nuevos, los que tienen pase turístico, placas foráneas o con placas formadas por letras, les aplica la misma restricción que a los vehículos que portan holograma 2.
Restricción a la circulación del 50 por ciento de las unidades de reparto de gas L.P. a tanques estacionarios, que no cuenten con válvula de desconexión seca, cuya terminación de matrícula sea non.
Los vehículos de carga local o federal, dejan de circular entre las 6:00 y las 10:00 horas, con excepción de aquellos que se encuentren en el Programa de Autorregulación de la CDMX o del Edomex.
Los taxis con holograma de verificación “00”, “0”, “1” o “2” que deban dejar de circular de acuerdo a las disposiciones indicadas en los incisos 1), 2), y 3), les aplicará La restricción a la circulación de las 10:00 a las 22:00 horas.

La Fiscalía aseguró que se le señaló a Alessandra que la carpeta físicamente se encuentra en el Estado de México y será posible tenerla en las siguientes 48 horas.
Fiscalía asegura que existe carpeta de Rojo de la Vega, aunque le niegan el acceso
L Mediante un comunicado, la Fiscalía capitalina informó que la carpeta de investigación del atentado en contra de la candidata Alessandra Rojo de la Vega, se encuentra en la Fiscalía General de Justicia del Estado de México (FGJCDMX) y es posible consultarla luego de 48 horas de haberse iniciado. Sin embargo, dicha información no fue precisada a la víctima cuando visitó las instalaciones la tarde del pasado viernes. No obstante, la carpeta de investigación iniciada por la Fiscalía de Investigación del Delito de Homicidio de la Coordinación General de Investigación Estratégica, la cual se inició debido al ataque del que Rojo fue víctima el 11 de mayo.
Según la Fiscalía puede ser consultada cuando así lo considere, ya se encuentra radicada en la Coordinación General de Investigación Territorial, donde se dio vista a la Asesoría Jurídica de la vícti-
ma, aunque el expediente del cateo donde se detuvo a Juan “N”, está resguardado. Conforme a la institución, para solicitar una orden de cateo en otra entidad, se requiere presentar la carpeta de investigación para que de ser autorizada por la autoridad judicial, las personas e indicios asegurados deberán diligenciarse en dicha carpeta de investigación y una vez concluidos se remiten a la Fiscalía solicitante.
Por ello, la Fiscalía aseguró que se le señaló a Alessandra que la carpeta físicamente se encuentra en el Estado de México y será posible tenerla en las siguientes 48 horas.
A pesar del dicho de la Fiscalía, Rojo acusó que solamente se le informó el plazo en el que podía consultar la carpeta, aunque nunca le explicaron en que unidad territorial se encontraba, por el contrario, el único argumento otorgado fue que debe de confiar en las autoridades. (Jorge Aguilar)
Fue detenido Kevin “N”, hijo del fallecido Felipe “N”, alias “El Ojos”, exdirigente del grupo delictivo “El cártel de Tláhuac”, en posesión de más de 200 dosis de posibles narcóticos, además de un arma de fuego corta y una larga tipo subametralladora.
La Secretaría de Seguridad Ciudadana (SSC) informó que durante un recorrido de vigilan-
cia, los oficiales se percataron que en la calle Juan de Dios Peza, de la colonia Gutiérrez Nájera Fividesu, de la alcaldía Tláhuac, dos sujetos manipulaban envoltorios como los que son utilizados para la distribución de droga. Cuando los oficiales les realizron una revisión, les aseguraron 102 dos bolsitas marihuana, 99 dosis de cocaína, un arma de fue-
go corta, un cargador y 14 cartuchos útiles, un arma de fuego tipo subametralladora abastecida con 11 cartuchos útiles, dos cangureras y dinero en efectivo.
Por lo anterior, “El Kevin”, de 22 años de edad y la otra persona, fueron detenidos y presentados, junto con lo asegurado, ante el agente del Ministerio Público correspondiente, quien definirá

Al “Kevin” se le acusa de integrar el cártel que se dedica a la extorsión, cobro de piso, tráfico de armas, homicidio y narcomenudeo.
su situación legal e integrará la carpeta de investigación del caso.
Al “Kevin” se le acusa de integrar el cártel que se dedica a la extorsión, cobro de piso, tráfico de armas, homicidio y narcomenudeo.
En el 2018, el hombre fue detenido junto a sus primos, cuando participó en un ataque armado contra policías, momento en el que fue acusado por portación de armas de uso exclusivo del ejército, delitos contra la salud y daño en propiedad pública y fue internado en un centro de reclusión para menores hasta el año 2020. (Jorge Aguilar)
En el video, la abuela de la niña se espanta de que se llevaron a su nieta y dice desconocer la identidad del secuestrador, aunque horas después, la madre aceptó que ella fue quien acudió al domicilio para sustraerla
La menor Kelly Anahí fue sustraída de su domicilio el pasado 16 de mayo, en la colonia Fuentes Brotantes de la alcaldía Tlalpan; en el video de la cámara de seguridad de la casa, donde vive con su padre, se observa cómo mientras permanece en una convivencia con su abuela materna en el jardín, una persona corre hacia la reja, la carga y se la lleva.
La menor estaba con su abuela dado que ante el divorcio de sus padres, se le dio a la señora la oportunidad de convivir con su nieta, sin embargo, al momento del rapto, la mujer acerca a la niña a la salida y se toma el tiempo de cerrar la reja y después, avisarle a los demás habitantes que se habían llevado a Kelly.
“Pilar, se llevaron a la niña”, le grita la señora a la otra abuela, quien habita la casa. “No puedes hacer eso, ¿Dónde está? ¿Cómo? ¡No!”, contesta.
ABUELA HABRÍA ACTUADO EN COMPLICIDAD
Ante ello, el padre de la menor acudió a la Fiscalía General de Justicia de la Ciudad de México (FGJCDMX) a levantar una Alerta Amber y una denuncia en contra de la abuela, ya que de acuerdo con ellos, luego del secuestro, corrió detrás de la persona y el vehículo que abordó, sin que la señora regresara o se conociera su paradero, lo que especuló que actuó en complicidad con los presuntos secuestradores.
Además, la familia de la menor narró que la abuela se contradijo al decir que desconocía a la persona que sustrajo a la niña y gritó como si se tratara de una persona desconocida.
En ese momento, se abrió la carpeta de investigación número CI-FICOY/CU/ UI-1 S/D/00046/05-2024 por el delito de sustracción de menores o incapaces y la alerta fue difundida en distintos medios de comunicación, lo que viralizó el

caso. Los afectados narraron que al revisar los videos de las cámaras de vigilancia, se les comunicó que el vehículo en el que aparentemente iba la menor, se había dirigido a la alcaldía Miguel Hidalgo, donde se le perdió el rastro.
“La reja de la casa solamente se abre con llave o desde adentro; la denuncia fue contra la abuela porque no supimos nada de ella después de que salió a perseguir el carro, no contesta llamadas ni se puso en contacto. Cuando se emitió la alerta, toda la familia se desapareció, la madre de la niña no contestaba, ella vive en Naucalpan, pero la cobertura de la cámara del C5 se ve que la camioneta llega a una calle en Miguel Hidalgo, después no se observa más”, relató a Crónica Jennifer, familiar de Kelly.
MADRE ACEPTÓ EN REDES SOCIALES QUE SE LLEVÓ A LA NIÑA, AUNQUE LA LEY LO PROHÍBE
Horas después, la madre de la niña, de nombre Regina, publicó en las redes sociales que su hija estaba con ella, acompañado de un texto en el que explica que decidió llevársela, debido a que estaba inconforme con el horario y lugar de las convivencias.
Sin embargo, desde el 2013, la Primera Sala de la Suprema Corte de Justicia de la Nación (SCJN) determinó que la sustracción de menores llevada a cabo por un familiar que no tiene la custodia legal es un delito constitucional; es decir, es obligación notificar a las exparejas dónde se encontrará el infante y en qué condiciones, dado que la Ley ubica los derechos e integridad de los menores como prioridad y de violarse, afectaría su sano desarrollo.
Para definir el régimen de convivencia, un juez debe tomar en cuenta la edad, necesidades y costumbres de los menores, así como el tipo de relación con el padre o madre que no tenga la custodia, los orígenes del conflicto familiar e incluso la disponibilidad y personalidad del padre no custodio y la distancia geográfica entre ambos hogares.
Aunque en este caso, está por resolverse la custodia, también se obliga a reportarle a la expareja las condiciones de la niña.
Asimismo, la SCJN estableció que tanto mujeres como hombres están capacitados para atender a hijos menores de 10 años, por lo que ambos pueden solicitar y obtener la custodia.
FISCALÍA DIJO QUE FUE FALSO, AUNQUE EL PADRE NO SABÍA DÓNDE ESTABA SU HIJA Ante las publicaciones de Regina, la FGJCDMX emitió un comunicado en el que calificó como falso el presunto secuestro de Kelly, aunque no detalló los pormenores de la investigación, ni que la sustracción fue planeada por su madre, sin que su padre u otras personas cercanas fueran avisados mientras la niña era buscada cuando se desconocía su paradero.
“Agentes de la Policía de Investigación trasladaron a la menor Kelly Anahí a la Fiscalía de Investigación de Delitos Cometidos en Agravio de Niñas, Niños y Adolescentes, al ser localizada, en buen estado de salud. La versión que surgió de la difusión de un video en redes sociales, sobre que supuestamente fue secuestrada o privada de la libertad, es falsa. La situación se originó de una controversia familiar, que motivó la
Todo lo ocurrido respecto al secuestro el 16 de mayo quedó grabado en la cámara de seguridad de la casa.
emisión de una Alerta Amber”, mencionó la institución en su cuenta de X.
Tanto el padre como los demás familiares, se enteraron del hallazgo mediante la publicación, sin que las autoridades les notificaran. Por ello, acudieron a la Fiscalía de Menores y Adolescentes, donde Kelly se encontraba en resguardo junto con la madre, mientras tanto, ni la madre o la abuela fueron sancionadas o señaladas por participar en un presunto montaje, a pesar del video donde la abuela grita que fue secuestrada, sin mencionar que fue su propia hija, hecho que probablemente incurre en un delito.
Además, mientras la niña se encontraba con su madre, el padre realizó la búsqueda junto con las autoridades y jamás fue avisado de la localización de su hija ni de su estado.
“Quedó en duda la difusión de cómo se la llevaron, aunque está el video y Regina aceptó en sus publicaciones que fue por la niña con sus propios medios, la abuela no puso resistencia, por eso la denuncia fue contra ella y se tenía que proceder de manera penal, porque andaba desaparecida”, esto fue una sustracción directa en el domicilio del menor, por eso actuamos de esa manera, relató Jennifer.
Al momento, la publicación de la FGJCDMX asegura que es falso el presunto secuestro, sin embargo, ello pone en duda el dicho del padre, quien presentó la denuncia, sin que se le de la oportunidad de aclarar que durante más de 24 horas, no sabía dónde estaba su hija y que ello lo llevó a solicitar una Alerta Amber para apegarse al procedimiento normativo.
“Los

Y estos obstáculos son para hombres y mujeres, añade el escritor chileno. Cuando tomas decisiones pierdes muchas cosas: amistades, pertenencias, poder, pero ganas libertad y terminas siendo la persona que quieres ser, añade
Entrevista
Eleane Herrera Montejano @EleaneHerrera“Los hombres que no fui” (Alfaguara, 2022) es una novela que habla de nuevas masculinidades y de algunas miles de trampas para no salir de la masculinidad patriarcal, así como de la manera en que el protagonista va surcando sus propias decisiones para convertirse en quien sí es.
“Es un libro sobre las trampas que existían para mantenerte dentro de la opresión patriarcal, ta nto hombres y mujeres”, ahonda el autor.
Mientras los colegas de otros medios de comunicación instalan sus cámaras y micrófonos, el escritor chileno Pablo Simonetti (1961) platica con Crónica sobre su reciente publicación.
Además de ser escritor, docente y promotor literario, Pablo Simonetti es activista en favor de los derechos de las minorías sexuales.
“Hay un mensaje, no sé si de esperanza, pero hay que decir que al ir tomando decisiones uno va perdiendo muchas cosas: pierde amistades, pertenencias, poder, pero al mismo tiempo va ganando su propia libertad y termina pudiendo ser la persona que cree que honestamente es”, comenta respecto de la intención del tono.
“Para las personas homosexuales, claro, pero también ahora creo que esto
se representa muy bien en las personas trans, que están viviendo más o menos esa misma etapa que vivimos nosotros en los 90: luchar contra todas estas prejuiciosas ideas preestablecidas, para finalmente poder llegar a la identidad con la que me identifico”, agrega.
La novela está contada en relatos, cada capítulo lleva el nombre de un personaje: Carmen, Andrés, Cristóbal, Samuel y Antonio, Luz y Gonzalo, Yael, Javier, Clarisa, Julián, Lucrecia, Luisa, Alberto, y Pedro; cuya historia es parte de la vida del protagonista y puede ser leída por sí sola o en conjunto con las otras.
El autor califica: “es una novela, pero a la vez cada capítulo es un relato en sí mismo porque es respecto de un personaje en particular, en relación con el personaje principal. La estructura es lo que me dio toda la libertad para ir generando el lenguaje sin ningún esfuerzo”.
EL ORIGEN
“Fui a un remate de antigüedades, una subasta que ocurrió en una casa en la que yo viví”, relata el autor, sobre la misma subasta que se describe en el libro, como punto de partida.
Sentados bajo una sombrilla en el jardín de un hotel en la CDMX, en el primer turno -de ese día- de un carrusel de entrevistas programado con antelación, Pablo Simonetti comparte los detonantes de esta novela.
“Había salido en el diario que esta era la colección de antigüedades más grande que habían rematado en la historia en Chile -por lo menos entonces- bueno,
fui a verla y tuve un encuentro como los encuentros que se dan en el libro”.
En los recuerdos de Pablo Simonetti vive un personaje que se apareció en aquel evento, pomposamente vestido, con una voz “muy trabajada”, diciendo cosas como “voy a comprar la colección de opalina y ese sillón donde conversaba tanto con el dueño de la casa…”
“Pensé que yo podría haber sido como él, una persona atrapada en un papel, una forma de ser gay, que en su momento me pareció sumamente válida porque era una defensa contra la mordida machista, tú te hacías el culto, el de buen gusto, trabajar en áreas como anticuario, diseñador o como peluquero o lugares donde la bestia machista tuviera menos posibilidad de entrar”, elabora. Desde su perspectiva, entrar en personaje protegía y daba cierto grado de autonomía o “poder” -”muy entre comillas”- mientras la lucha por los derechos avanzaba. “El espacio se abrió entonces ese personaje se volvió algo anacrónico, porque en el fondo es un personaje forzado por las circunstancias que han ido cambiando”.
“Eso me hizo pensar encontrarme con otra gente de esa época, que hablara también de otras formas de masculinidad a las cuales yo podía haberme apegado: haber tenido una novia y esposa y ocultar su sexualidad o haber sido muy de derechas, de empresas o también podía haber estado del lado de las víctimas y tuve suerte de no estarlo -de haber tenido VIH o un problema de salud mental que me llevara al suicidio”, continúa. Con base en estas reflexiones sobre

“Fui a un remate de antigüedades, una subasta que ocurrió en una casa en la que yo viví”, relata el autor, sobre la misma subasta que se describe en el libro
los hombres que pudo haber sido y no fue, el autor parte de un encuentro real, en la subasta, y lo complementa con una serie de personajes ficticios, que sintetizan a personas que conoció en la vida real.
“Empecé a diseñar a los personajes que se va a encontrar el protagonista. Todos son como una torta de mil hojas de personajes reales, los diálogos son ficticios”.
En el epígrafe de la novela, Pablo Simonetti dedica esta novela a sus “amigos muertos”.
¿Estos amigos a los que refieres son todos estos hombres que no fuiste? “En realidad, me refiero a personas que

fueron enfrentando todos los desafíos de esa época a la cual se remite la novela: el día del estallido social del 2019, pero siempre remitiendo a una época pretérita, los años 90”.
En esos años, el escritor refiere que hubo una crisis de SIDA en Chile, así como una serie de casos de personas que no podían aceptar su propia homosexualidad y se suicidaron, entre muchas otras victimas del miedo y odio, que también terminaron muertas.
“También hubo muchas situaciones de mujeres que fueron víctimas y no terminaron muertas, qu izás una mejor dedicatoria hubiera sido a mis amigos que fueron víctimas”, bromea y retoma.
“Fue una época de expansión para Chile en términos políticos, veníamos saliendo de la dictadura, en una transición democrática, pero igual en esa transición democrática hubo muchos temas que se mantuvieron bajo una presión social muy grande, como la homosexualidad y la feminidad alternativa al modelo patriarcal, VIH”.
Asimismo, Pablo considera que la necesidad y deseo de consenso en la conversación pública de ese momento dificultó alzar estos temas en la agenda
Además de ser escritor, docente y promotor literario, Pablo Simonetti es activista en favor de los derechos de las minorías sexuales.
pública. “Eso hacía que todo esto ocurriera bajo un manto de silencio, todas estas injusticias”.
¿QUIÉN ES EL ESCRITOR?
Pablo Simonetti (Santiago, Chile, 1961) estudió Ingeniería Civil en la Universidad Católica de Chile y un máster en Economía por la Universidad de Stanford. Además de ser escritor es conocido por su activismo a favor de las minorías sexuales en su país.
De acuerdo con la semblanza de Penguin Random House, Simonetti se dio a conocer al gran público tras resultar ganador del concurso de cuentos de la revista Paula. Tres años después vio la luz su primera antología, Vidas vulnerables, y en 2004 logró su primer gran éxito de ventas con Madre que estás en los cielos, novela a la que han seguido otros títulos como La soberbia juventud, Desastres naturales o Los hombres que no fui.
Su obra ha sido traducida a varios idiomas y es colaborador de varios medios de comunicación, como El Mercurio o La Tercera. Además de escribir imparte clases de Escritura Creativa y es un conferencia habitual en actos dedicados a la cultura .
INEGI: Más de 48 millones de personas visitaron museos durante el 2023

Museo Nacional de Antropología.
Durante el 2023, los museos en el país reportaron la visita de 48.4 millones de personas y las ciudades donde mayo afluencia hubo son la Ciudad de México, con 22.2 millones en 148 museos y Nuevo León, con 4.7 millones en 48 museos y la afluencia total aumentó 10.8 millones respecto al 2022, señala el INEGI.
La institución señala, en un comunicado, que son los resultados de su informe Estadística de Museos (em) 2023, “información que proviene de la infraestructura y características de los museos, así como de las características sociodemográficas de sus visitantes”.
El INEGI explica que, respecto a la entrada a estos recintos, en el 59.0 % fue gratuito, 22.9 % cobró una cuota de ingreso y 18.1 % aplicó la gratuidad algunos días de la semana. Estos porcentajes son similares a los de 2022.
Para este 2023, el 88.1 % de los museos contó con servicio de visitas guiadas y 49.0 %, con actividades artísticas y culturales, escenario que también se presentó en 2022, con 87.2 y 46.5 %, respectivamente. Además, 34.6 % de los museos contó con infraestructura para personas con discapacidad y 31.9 %, con servicio de wifi.
En el periodo referido, 29 071 personas laboraron en los museos y del total del personal ocupado, 36.2 % es voluntariado y servicio social.
La Ciudad de México, con 22.2 millones en 148 museos, la mayor afluencia, y le sigue
Nuevo León, con 4.7 millones en 48 museos
PERFIL DE LOS VISITANTES
De las personas que visitaron museos en 2023, 59.4 % contó con escolaridad de nivel superior y 26.9 %, de nivel medio superior. Estos porcentajes son similares a los valores de 2022. Respecto a la causa de por qué no se asiste a los museos, los principales motivos fueron: falta de difusión y publicidad o desconocimiento del acervo que ofrecen (18.0 %), falta de cultura o de educación (17.0 %), y porque no tiene tiempo (15.7 %). En 2022, los principales motivos para no visitar los museos fueron los mismos.
De las personas visitantes, 66.0 % recibió algún estímulo familiar durante la infancia para visitar museos o recintos similares; 33.8 % manifestó no haberlo recibido. Los porcentajes son similares a los reportados para el año anterior.
Al momento de la entrevista, 81.0 % de las personas visitantes dijo que era la primera vez que visitaba el museo, 12.0 % lo visitó dos o tres veces y 7.0 % realizó cuatro o más visitas en los últimos 12 meses.
La permanencia en el museo fue menor a una hora para 57.7 % de las personas visitantes . (Redacción)

La cámara más silenciosa del mundo es propiedad de la empresa Microsoft, pero la de la UNAM es muy similar
Ciencia UNAM
Elisa Domínguez Álvarez-Icaza
Ciencia UNAM-DGDC*
Estamos en el interior de una cámara anecoica: un cuarto aislado con paredes cubiertas de hule espuma que absorben las ondas acústicas e impiden su reflexión. Este es a la vez un laboratorio. Dentro, el silencio es impresionante, lo que permite medir la intensidad de diversas fuentes de sonido como la voz humana o un instrumento musical en diferentes direcciones y frecuencias, así como detectar las características de receptores como los micrófonos.
La cámara más silenciosa del mundo es propiedad de la empresa Microsoft. Al compararla con la que se encuentra en el Instituto de Ciencias Aplicadas y
Tecnología, “la sensación perceptual es prácticamente la misma, en ambas el umbral auditivo humano queda por arriba; es decir, el nivel mínimo que escucha el humano es varios decibeles superior al nivel de sonido extremadamente bajo (silencioso) que hay ahí”, comparte el responsable del lugar, el doctor Felipe Orduña.
Para algunas personas, entrar en el cuarto provoca inquietud. Si estamos acostumbrados al ruido ambiental, imagina enfrentarte al completo silencio.
En el Laboratorio de Acústica y Vibraciones del Instituto de Ciencias Aplicadas y Tecnología (ICAT) también podemos visitar una cá mara de transmisión, un cuarto dividido en dos espacios por medio de una pared. En el primero, hay una fuente, y del otro lado, un receptor. Este sitio permite medir el nivel de sonido de la fuente y saber cuántos sonidos se transmiten a través del material del que esté hecho la pared para conocer su aislamiento sonoro. Así, a la hora de planear una construcción y ver la disposición de puertas y ventanas y los materiales que utilizarás, puedes saber qué pasará con el sonido.
También hay un tubo de transmisión a escala. Se pone una muestra de
Músico también
Entusiasta de la acústica
Felipe Orduña Bustamante se especializa en tecnología musical, en particular ha trabajado en el desarrollo de softwares con aplicaciones en algún aspecto de música. Algunos de sus proyectos tienen que ver con el uso de herramientas de minería de datos para explorar grandes corpus de músicas y extraer tendencias de fragmentos melódicos o de texto.
Junto con la doctora Eunice Padilla trabajó en un software de entrenamiento auditivo para la afinación de clavecines que ayuda a los estudiantes a adquirir una habilidad de escucha muy precisa.
Felipe tiene una faceta como músico, nos cuenta. “Cuando hago música tengo una perspectiva un poco más completa, por ejemplo de la influencia del recinto, la interacción del intérprete con el instrumento; la manera en que se combinan los instrumentos”.
Actualmente, Orduña trabaja en el desarrollo de una ventana cuyo prototipo está montado ahí. Es un modelo que tiene cavidades por donde pasa libremente el aire y a la vez un material que amortigua el sonido. El objetivo es lograr mayor circulación que una ventana cerrada, pero impedir la invasión de los sonidos exteriores.
Felipe participa en una orquesta de cuerdas que tocan música barroca
En su trabajo piensa en la música: Ha estudiado el funcionamiento físico de los instrumentos
La investigación toma como inspiración escenarios reales. En los salones de la Unidad de Posgrado, se sufre de un acaloramiento extremo o una perturbación constante de los ruidos de la avenida colindante. Dependencias del gobierno o universitarias frecuentemente necesitan mediciones del ruido y las vibraciones y propuestas de acondicionamiento acústico que puede proveer el laboratorio.
material en medio, en un portamuestras y funciona bajo el mismo principio que la cámara, sin embargo, en el tubo, el sonido llega de forma perpendicular mientras que en la cámara, el sonido llega en dirección de propagación de incidencia aleatoria, desde distintos ángulos.
Además hay dos cámaras reverberantes, una grande y otra más pequeña, donde se determinan las propiedades acústicas de diversos materiales. La industria automotriz es cliente de estos servicios para determinar caracterizaciones de los materiales en términos de absorción del sonido.
En México, lamentablemente hay pocas oportunidades de estudiar temas de acústica, que se incrementan conforme se especializan los estudios, comparte el doctor. Puedes llegar ahí desde diferentes áreas, como la física, la ingeniería electrónica o mecánica. Después puedes incursionar en la docencia, en la producción musical, las industrias tecnológicas, en la arquitectura, entre otras áreas. El mundo de la acústica es extenso y más cercano de lo que pensamos. Está en el aparato que reproduce música diariamente, en los materiales que usamos en nuestra casa o en la manufactura de coches. Incluso en el sueño de volverte un artista, un científico, o ambos .
* Colaboración de la Dirección General de Divulgación de la Ciencia de la
Reducen su eficiencia con la que puede eliminar el dióxido de carbono de la atmósfera: estudio
Europa Press academia@cronica.com.mx
Los microplásticos pueden reducir la capacidad del océano para ayudar a compensar la crisis climática al disminuir la velocidad a la que se extrae carbono de la superficie del mar a las profundidades.
Es la conclusión de un nuevo estudio publicado en la revista Marien Chemistry, del que es autor el investigador Aron Stubbins de la Universidad de Northeastern.
Durante milenios, el océano ha sido parte de un proceso de sumidero de carbono en el que el fitoplancton muerto se agrupa y cae a las profundidades del océano en lluvias de lo que parece “nieve marina”, dice Stubbins, profesor de ciencias marinas y ambientales.
El secuestro de carbono resultante es una versión marina de cómo los árboles y las plantas de la Tierra terrestre toman carbono de la atmósfera y lo almacenan en el suelo, afirma en un comunicado.
Pero la investigación muestra que los microplásticos en el océano están ralentizando el
proceso al hacer que la “nieve marina” sea más flotante, dice Stubbins.
“Los plásticos quieren flotar. Si el fitoplancton crece sobre microplásticos en biopelículas, en lugar de como organismos de vida libre, eso cambia la flotabilidad del fitoplancton cuando muere”, dice Stubbins.
“Básicamente, los plásticos están ralentizando el ritmo de hundimiento de la nieve marina, lo que potencialmente reduce la eficiencia con la que el océano puede eliminar el dió -
aceleran
Junto con el calentamiento general del planeta, las tormentas eléctricas han acelerado directamente el actual proceso de retroceso del hielo marino que cubre el Océano Ártico.
Según un nueva investigación, publicada en Atmospheric Research, “hasta hace poco, los rayos como fenómeno eran extremadamente raros en la región ártica del Polo Norte debido al intenso frío. Sin embargo, debido al calentamiento de la Tierra, las tormentas eléctricas
se han vuelto más comunes allí en el veranos, y estas tormentas aumentan aún más el proceso de derretimiento de las capas de hielo, en un circuito de retroalimentación”.
Uno de los autores de la investigación, el profesor de Ciencias del Medio Ambiente y la Tierra de la Universidad de Tel Aviv Colin Price, explica en un comunicado: “La región ártica se define como la región situada al norte de los 66,5° de latitud. En el corazón
xido de carbono de la atmósfera”, afirma.
Para el estudio, los investigadores cultivaron el diminuto plancton unicelular en tanques con y sin exposición a microplásticos.
Luego llevaron a cabo su propia versión de una carrera hacia el fondo. Colocaron grupos regulares de fitoplancton en un cilindro medidor lleno de agua de mar y colocaron el fitoplancton entrelazado con microplásticos en otro cilindro.
“Se cronometró la rapidez con
de esta región, alrededor del Polo Norte, no hay tierra y, debido a las condiciones de frío extremo, el mar está cubierto por una gruesa capa de hielo marino, que actualmente se extiende sobre unos 8 millones de kilómetros cuadrados. El hielo blanco refleja los rayos del sol y contribuye así al enfriamiento de la Tierra.
“Pero en las últimas décadas, con el calentamiento de la Tierra, la capa de hielo ha retrocedido a un ritmo de unos 70.000 kilómetros cuadrados por año, o un 6,5% por década (en este contexto, es importante señalar que la temperatura en el polo norte ha ido ascendiendo a un ritmo acelerado (alrededor de
en colaboración con la Universidad de New Hampshire, muestra que la desaceleración del ritmo de descenso de la nieve marina mezclada con microplásticos llega en un momento en que el secuestro de carbono es más importante que nunca.
“A medida que ese carbono se hunde, es transportado a zonas más profundas del océano”, dice Stubbins. “Es muy importante saber en qué medida el océano compensa el calentamiento debido a las emisiones humanas de dióxido de carbono”.
MENOS NUTRIENTES ATLÁNTICO
El calentamiento global puede provocar una disminución de los nutrientes y la actividad biológica en el Atlántico Norte debido a un debilitamiento de la circulación oceánica.
Investigadores del Instituto de Tecnología de Georgia han terminado de investigar cómo el debilitamiento prehistórico de la Corriente del Golfo provocó una disminución de los nutrientes del océano y efectos negativos en la vida oceánica del Atlántico Norte.
Para el estudio, los investigadores cultivaron el diminuto plancton unicelular en tanques con y sin exposición a microplásticos
la que se hundieron», dice Stubbins. “Los de plástico fueron más lentos, alrededor de un 20%”. Dice que el estudio, realizado
4° hasta hoy, en contraste con aproximadamente 1° en la Tierra en su conjunto).
“La retirada del hielo aumenta aún más el calentamiento, porque las zonas oscuras del océano bajo el hielo, cada vez más grandes, absorben los rayos del sol que normalmente se reflejarían en el espacio. Así se crea un circuito de retroalimentación: la retirada del hielo aumenta el calentamiento, lo que a su vez aumenta el derretimiento del hielo, y el ciclo se repite”.
Según los investigadores, el fenómeno del derretimiento de las capas de hielo en ambos polos se atribuye en primer lugar al resultado de la
El océano Atlántico Norte es un centro de actividad biológica, debido en gran parte a la Corriente del Golfo, que suministra una rica corriente de nutrientes. Hasta ahora, la teoría de que un debilitamiento en la corriente supondría una reducción de nutrientes sólo había sido respaldada por modelos. Ahora, al estudiar los sedimentos enterrados en el origen de la Corriente del Golfo, el equipo ha llevado a cabo una investigación, la primera de su tipo, sobre el impacto de un declive similar inducido por el clima hace casi 13 mil años, cuando la Tierra salió de la última edad de hielo. Los resultados se publican en Science .
actividad humana debido al aumento de la cantidad de gases de efecto invernadero en la atmósfera, creando una especie de “manta” que preserva el calor y no permite que se disperse en el espacio. Sin embargo, los estudios no han encontrado una coincidencia directa entre los cambios de gases de efecto invernadero, que aumentan a un ritmo más o menos constan te cada año, y el ritmo de derretimiento del hielo marino, que varía enormemente de un año a otro. Este estudio pretendía examinar el posible efecto de otro factor (las tormentas eléctricas) en el derretimiento del hielo marino en la región ártica .
El gobernador de Florida se ha convertido en la punta de lanza del movimiento que se opone a combatir el calentamiento global y se niega a entrar en razón
Fran Ruiz mundo@cronica.com.mxEl gobernador de Florida, Ron DeSantis, firmó el miércoles una iniciativa que no sólo niega el cambio climático, sino que fomentará el uso de gas como combustible y prohibirá la inversión en centrales eólicas en el mar, pese al enorme poten cial en generación eléctrica por sus vientos casi constantes en uno de los estados con más costa de Estados Unidos.
“Estamos restaurando la cordura en nuestro enfoque energético y rechazando la agenda de los fanáticos verdes radicales”, dijo DeSantis en un mensaje desafiante en la red social X, en el que deja claro que los enfermos mentales y los intransigentes son la práctica totalidad de los científicos, los ecologistas, activistas y gobernantes de más del 90% del planeta —incluido el presidente de EU, Joe Biden—, que conspiran, según el gobernador, para destruir la industria del petróleo y el carbón, a la que rinden pleitesía porque son grandes donantes del Partido Republicano, como en su día lo fue la industria del tabaco o lo sigue siendo la industria de las armas.
La iniciativa, que entrará en vigor el 1 de julio, también elimina el requisito de que las agencias gubernamentales lleven a cabo conferencias y reuniones en hoteles certificados como “alojamientos ecológicos” por la agencia medioambiental del estado, y que las agencias gubernamentales den prioridad a la eficiencia energética en la compra de nuevos vehículos.
Además, pone fin al requisito de que las agencias estatales de Florida consulten una lista de productos “respetuosos con el clima” antes de realizar sus compras.
Sin esperar a que la ofensiva anticlimática entre en vigor en mes y medio, la web del Gobierno de Florida ya ha eliminado de su apartado sobre Recursos Energéticos la frase que señalaba que «los impactos del cambio climático global pueden reducirse a través de la reducción de las emisiones de gases de efecto invernadero».
¿CALOR RÉCORD? SÍ ¿Y?
El mismo día que el gobernador republi-

cano borró de toda documentación oficial la palabra “cambio climático!”, como sí así dejara de existir el problema, Florida sufría una ola de calor con temperaturas récord, como en Cayo Largo, donde la combinación de humedad y calor creó una sensación térmica de 46.6° centígrados, un récord histórico.
Y como el calentamiento global no entiende fronteras, al otro lado del estrecho de Florida, en la isla de Cuba se batió otro récord alarmante: por primera vez desde que hay registros, la isla alcanzó los 40 grados y ocurrió sólo un día, sino dos veces, como si fuera un presagio apocalíptico de que esta va a ser la nueva realidad, como ya la están viviendo los millones de brasileños afectados por las inundaciones históricas en el sur del país o los enormes incendios en Canadá, cuya temporada se adelanta año con año.
El miércoles de la firma, prácticamente en todas las ciudades de Florida se alcanzaron temperaturas propias de verano, cumpliendo así el peor pronóstico de los expertos, que temen una temporada de huracanes particularmente intensa y destructiva, debido a este inusual calentamiento temprano de las aguas del golfo de México, del Caribe y del Atlántico.
Pero, ¿qué se puede esperar de un gobernador que negó también la gravedad de la pandemia, contribuyó a difundir el bulo de que las vacunas contra la covid-19 era
inocuos o incluso dañinas e hizo todo lo posible para que no se distribuyeran masivamente en el estado? ¿Por qué precisamente el gobernador de Florida, uno de los estados más vulnerables al cambio climático, por su exposición directa a huracanes y con gran parte de su territorio casi al nivel del mar, es el que echa más leña al fuego del negacionismo? Y la pregunta clave: ¿Por qué hay tantos negacionistas no cambian de opinión aunque se demuestre que están equivocados?
EL EFECTO “MANCHA DE ACEITE” Dolores Albarracín, profesora de psicología social de la Universidad de Illinois, explica el negacionismo con el siguiente símil: “El negacionismo es como una mancha de aceite: es más fácil manchar que quitar la mancha”, sobre todo si esa mancha “coincide con nuestra visión del mundo, con nuestra escala de valores”, lo que hace que sea mucho más difícil eliminarla, en muchos casos, imposible. Explicado así, ¿quién no se ha aferrado a una mentira, a sabiendas de que no era cierto o no tenía suficientes elementos para defender su postura?. El problema es cuando el negacionista está en una situación de poder y lo ejercita para imponer sus dogmas (verdades absolutas), sin importarle que sean ciertas o no, o el daño que puedan provocar. Un ejemplo sangrante sobre el efecto perverso del negacionis-
mo fue la industria farmacéutica estadounidense, que durante décadas negó que analgésicos potentes como Oxycontin o Vicodin contuviera opioides y la consecuencia fue que cientos de miles de estadounidenses se convirtieron en drogadictos. En el caso de DeSantis, su visión del mundo no sólo consiste en identificar quiénes son sus enemigos, sino en atacarlos sin piedad, y en su caso, sin lógica. El enemigo del gobernador Florida es lo que el mundo ultraconservador denomina despectivamente como la ideología o el movimiento “woke”, cuyo origen se remonta al “despertar” de los negros para denunciar hechos discriminatorios raciales. Con el tiempo pasó a englobar cualquier forma de estar “alerta” contra la injusticia, pero casi de inmediato la derecha contraatacó imponiendo el vocablo “antiwoke”, para burlarse o atacar toda forma de activismo que amenace su mundo tradicional, conservador y supremacista blanco: las minorías raciales, los grupos antiarmas, los movimientos homosexuales o feministas, o los liberales progresistas, a los que directamente llaman “comunistas”.
El último frente de batalla es contra los ambientalistas y, dada su trayectoria intransigente, nada lo hará cambiar de opinión, como tampoco cambiarán de opinión la mayoría de sus votantes… aunque se empiecen a inundar sus casas con la subida inexorable del nivel del mar .
El partido ultra Vox convoca a Milei, Le Pen, Kast, con la participación virtual de la italiana Meloni y el húngaro Orban
Agencias
Madrid
Este domingo 19 de mayo, la ciudad de Madrid se convertirá en el escenario de dos eventos significativos y opuestos: por un lado, la cumbre de líderes de la extrema derecha organizada por Vox en Vistalegre, y por otro, una manifestación enérgica liderada por colectivos de mujeres que ocuparán la Plaza de Colón para denunciar y contrarrestar esta reunión.
Este contrapunto no solo destaca la polarización política actual, sino que también subraya la urgencia de defender los derechos humanos y los valores de -
mocráticos frente a un fascismo cada vez más audaz.
CUMBRE DE EXTREMA DERECHA
Los líderes de la extrema derecha que se darán cita en Madrid incluyen figuras como el presidente argentino Javier Milei, la francesa Marine Le Pen, el polaco Mateusz Morawiecki o el chileno José Antonio Kast, con la participación virtual de la primera ministra italiana Giorgia Meloni y el primer ministro hungaro Viktor Orbán.
Este encuentro ocurre en un momento crucial, justo un mes antes de las elecciones europeas, lo que sugiere un intento de fortalecer y consolidar una agenda política que muchos consideran peligrosa para el tejido social y los principios de igualdad y libertad.
Al tratarse de una especie de reunión internacional de las fuerzas vivas de la extrema derecha, sus simpatizantes se movilizaron desde diversos puntos del continente y, por supuesto de España, hasta Madrid para escu-
El papa abraza a israelí y a palestino que perdieron familiares en la guerra
El papa Francisco abrazó este sábado a un israelí y un palestino que han perdido familiares en la actual guerra, que tachó de “derrota histórica”, durante un acto por la paz en la ciudad italiana de Verona (norte).
El Pontífice argentino reunió a unas 12 mil 500 personas en el famoso anfiteatro romano veronés, la Arena, en un evento sobre la paz en el que, entre otras cuestiones, abordó la guerra en la Franja de Gaza e Israel tras el ataque de los islamistas de Hamas del 7 de octubre. Entre los testimonios escuchados, destacó el caso del israelí Maoz Inon, que perdió a

char a sus líderes.
Algunas de las intervenciones más esperadas son las del argentino Milei, de la italiana Meloni, del húngaro Orban, de la francesa Le Pen, del chileno José Antonio Kast, del portugués Andre Ventura y del ministro israelí de Lucha contra el Antisemitismo, Amijail Chikli, y, por supuesto, del anfitrión español, Santiago Abascal, líder de Vox.
Los encuentros fueron organizados por la Fundación Disenso, el centro de pensamiento de la ultraderecha española, como las mesas de diálogo Cultura de la cancelación y Los medios de comunicación y el poder político.
“CUANDO NADIE ME QUERÍA ME ABRAZÓ ABASCAL”
Una de las visitas que más expec-
de abrazarse y esto no solo es valentía, sino ejemplo de querer la paz, es un proyecto de futuro, abrazarse”, celebró.
sus padres a manos de Hamas, y el del palestino Aziz Sarah, cuyo hermano fue asesinado por las tropas de Israel. Ambos hablaron ante el Papa y declararon haberse unido por “el dolor y el sufrimiento” que experimentaron, lo que hizo que todos los asistentes del anfiteatro se pusieran en pie y aplaudieran, también el propio papa a pesar de sus problemas de movilidad.
Francisco después abrazó a ambos: “Creo que ante al sufrimiento de estos dos hermanos, que es el sufrimiento de dos pueblos, no se puede decir nada. Ellos han tenido la valentía
El papa Francisco pidió entonces a los asistentes guardar silencio y rezar por la paz, especialmente por los niños y los ancianos, no solo de Tierra Santa sino también de Ucrania.
“Pensemos en los ancianos que trabajaron toda la vida para sacar adelante estos dos países y ahora esta derrota, una derrota histórica y de todos nosotros. Recemos por la paz y que estos dos hermanos lleven este deseo nuestro y la voluntad de trabajar por la paz a sus pueblos”, dijo.
El líder religioso llamó a los asistentes a “sembrar esperanza” y dijo “estar cada vez más convencido de que el futuro de la humanidad no solo está en manos de los líderes y de las grandes potencias sino también
tativa genera es la de Milei, sobre todo a raíz de la polémica con el gobierno español del socialista Pedro Sánchez, tras las acusaciones del ministro de Transportes español, Óscar Puente, de que el mandatario argentino consumía sustancias, y que provocó que el gobierno andino lo tildara de energúmeno. El viernes, Milei presentó su libro El Camino del Libertario, junto a un periodista de la derecha española y director del diario La Razón, Francisco Marhuenda, evento en el que Milei expresó agradecimiento a su anfitrión de Vox: “Cuando nadie me quería, el único que me abrazó fue Abascal. Era imperativo moral participar en el evento, pues, además, es un gran amigo, un gran ser humano”.
PROTESTA EN LA CALLE
“Frente a la intolerancia, a la fractura social y al odio hoy reivindicamos el poder de la democracia”. Este es el lema por el que cientos de manifestantes se han concentrado en la plaza Callao de Madrid en protesta al auge de la ultraderecha en el mundo.
“Vox y todo lo que va a venir aquí son fascismo y la historia ya nos ha mostrado las consecuencias”, advierte otro manifestante.
El presidente del Gobierno español, Pedro Sánchez, también ha criticado la convención de Vox. En un acto político en Barcelona junto al alcalde de Barcelona, Jaume Collboni; el líder del PSC y vencedor en las elecciones catalanas, Salvador Illa; y la vicepresidenta y candidata del PSOE a las europeas .

en las manos de los pueblos y en su capacidad de organizarse” y “cambiar”.
Asimismo, Francisco dijo que se respira “cansancio en el aire” de las sociedades y advirtió que “la paz no se inventa de un día para el otro, sino que debe ser cuidada”. Por eso, tachó
de “delito grave” que en el mundo actual no se cuide la paz. También denunció la situación de los “niños y niñas obligados a trabajar como esclavos para ganarse la vida”, que “nunca han tenido un juguete” y que “trabajan en vertederos buscando cosas que vender” .

El más reciente filme de Paul Schrader compite por la Palma de Oro del Festival de Cannes donde ha cautivado en su primera proyección
Corte y Queda en Cannes
Anne Hoyt en Cannes
X:@Anne Cine
Aunque el título se refiere a la línea geográfica que divide a Estados Unidos con el país del norte, el espacio que Paul Schrader captura es metafísico; el umbral entre la vida y la muerte, y también el horizonte moral y los límites que se violan en ese terreno.
A los 77 años, el cineasta y escritor que ganó una Palma de Oro por su guión de Taxi driver, en 1976, presenta en competencia un filme que, aunque modesto, refleja los principios de un cine que Schrader clasificó como trascendental en su libro Transcendental Style in Film: Ozu, Bresson, Dreyer (1972/2018).
Schrader escribe que lo que une en sus búsquedas temáticas y estilísticas a cineastas tan disímbolos como el japonés, Yasujirō Ozu; el francés, Robert Bresson y el danés Carl Th. Dreyer, es que todos investigan el “misterio de la existencia”. Oh, Canada es casi un cortometraje, un pequeño ensayo que igual contiene los grandes temas que ocupan a Schrader y a esos cineastas que tanto admira.
Oh, Canada es la segunda adaptación al cine que hace Schrader de una novela de Russell Banks. Después de la primera, (Affliction, 1998), se volvieron tan amigos que Schrader pasaba todos los veranos con el escritor y su familia en las montañas Adirondack al norte de Nueva York. Sin embargo, en 2022, Banks le pidió al cineasta que no fuera puesto que estaba sufriendo terriblemente los efectos de la quimioterapia por un cáncer recién detectado. Banks falleció en enero del 2023, y Schrader decidió llevar la historia a la pantalla y dedicársela a él.
Richard Gere, de 74 años interpreta al mucho mayor, Leonard Fife, quien sorprendentemente acepta ser entrevistado por dos exalumnos (Michael Imperioli y Victoria Hill) para un documen-

del filme.
tal. A pesar de los terribles dolores que lo aquejan y a estar reducido a una silla de ruedas, Fife recibe a los cineastas en el elegante apartamento en Montreal que comparte con su esposa de 30 años (Uma Thurman).
Fife insiste en que su esposa esté presente durante la entrevista, pero cuando ella se da cuenta que el anciano comienza a revelar detalles escabrosos de su vida, trata de retirarse. El insiste en que se quede puesto que lo que dirá ante la
cámara será su última oportunidad de confesarse; será su expiación. De hecho, describe la entrevista como “una última plegaria” y es necesario que ella lo escuche para obtener el perdón.
El momento seminal en la vida de Fife, y de donde viene el título del filme, es 1968 cuando huye a Canadá para evitar ser enviado a Vietnam. Alrededor de 60 mil jóvenes estadounidenses hicieron lo mismo durante los años que duró la guerra, pero no todos lograron
como Fife fincar los cimientos de su reputación en ese hecho. A partir de esa objeción moral a lo que Estados Unidos estaba haciendo en Asia, Fife comenzó a construir su leyenda de “artista comprometido”.
Esa fama lo acompañaría cuando ya como documentalista denunciaría con su lente injusticias similares. Algo parece querer decir Fife que derrocaría ese mito fundacional. Apenas si tiene fuerza para hablar, pero insiste en narrar las circunstancias en las que se encontraba cuando tomó la decisión de irse a Canadá.
A pesar de solo contar con 22 años, Fife ya había dejado varios rastros de dolor en su camino: dos matrimonios fallidos, hijos abandonados, seducciones y traiciones. A medida que va entrando en más detalles, la esposa se da cuenta de que, en su relato, Fife se está auto incriminando y poniendo en peligro su legado. Trata de pararlo, pero él insiste en no ahorrar ningún detalle que lo haga ver menos canalla de lo que en realidad fue.
Mientras habla, vemos la recreación de los hechos (interpretado de joven por Jacob Elordi). Fife piensa que esta especie de confesión va a ser la única forma de expiar una vida en la que vivió en “mala fe”, por usar el término acuñado por el Existencialismo de Sartre, tan de boga en esa época; es decir, fuera de sintonía consigo mismo.
El momento preciso en el que se encuentra Fife frente a la cámara, refleja la “paradoja de lo espiritual dentro de lo físico”, que “no puede ser ‘resuelto’ por ninguna lógica terrenal o acción humana”, como lo describe Schrader en su libro. El dolor físico y psíquico abre las compuertas de la autoconciencia y le da a Fife la última oportunidad de redención. Es solo en las entrañas del dolor cuando el hombre se enfrenta inevitablemente con su Verdad.
Schrader menciona La Muerte de Iván Ilich de Tolstoy como referente. En esa obra maestra, Tolstoy nos revela en todo su horror cómo un hombre irreflexivo que vivió su vida solo siguiendo lo que otros esperaban de “él se enfrenta a la hora de su muerte a su único momento de Verdad”.
La novela corta que Tolstoy escribió después de una profunda crisis espiritual, narra la historia de un juez que en el horno de la enfermedad que va consumiendo su cuerpo poco a poco, la verdad que se le escapó durante toda su vida se le aparece al fin en toda su claridad.
Es en las últimas horas de sus cuarenta y cinco años de vida que Ivan Ilych finalmente se vuelve uno consigo mismo. Schrader le da también a su personaje la posibilidad de redención, y nos lo revela con un mínimo detalle de exquisita belleza que solo el cine; el cine trascendental, podría capturar.
La cantautora venezolana que se presentará próximo 31 de mayo en el foro Bajo Circuito platicó con Crónica Escenario sobre su quehacer artístico, inspiraciones y referencias
Música
César Cárdenas
X:@gabolario7
Joaquina, cantautora venezolana ganadora del Latin Grammy 2023 a Mejor Nuevo Artista, se está preparando para su presentación del próximo 31 de mayo en el foro chilango de Bajo Circuito. Su más reciente sencillo vio la luz en marzo de este año, bajo el título “Escapar de mí”: una canción sobre las consecuencias de perdernos en nuestros adentros y perder la luminosidad de la realidad. Joaquina escribió el sencillo, que podrá escucharse en el setlist de su visita a México, en una época en la que necesitaba encontrarse de nuevo, mientras pasaba por una temporada en la que se estaba “autosaboteando demasiado” a través de sus pensamientos.
En entrevista para Crónica Escenario, Joaquina nos contó que se encuentra profundamente agradecida con sus seguidores, viviendo un día a la vez, aprendiendo y creciendo paso a paso. “Algo que tengo muy presente es seguir la intuición; he tenido que aprender a rasparme las rodillas” dijo Joaquina y añadió que un reconocimiento tan grande como el Latin Grammy, aunque se sintió como un impulso para el inicio de su carrera, se tiene que saber manejar, sobre todo para entender que es una avalancha de sentidos que poco a poco pasa y deja las cosas tal y como estaban antes de obtener el galardón.
La joven intérprete tiene hambre de crear su comunidad, de que su gente la escuche, de tener cercanía con su público, de ser solo ella. Sobre sus referencias y fuentes de inspiración recientes nos dijo que ha estado leyendo un poco de todo, aunque siempre le ha gustado la poesía, las letras de Isa-
Especial

bel Allende y las plumas de Pablo Neruda, Eduardo Galeano, Emily Dickinson o E.E. Cummings. Entre libros y composiciones, Joaquina pasa sus días acostumbrándose a los viajes para promocionar su material; está en medio de un proceso de construcción y creación más libre, permitiendo que su material nazca de todo lo que la rodea de forma perpetua.
“Hace poco estaba hablando con un amigo y me dijo que vale más hacer lo que puedas con lo que tienes pero hacerlo increíble a estar en una búsqueda constante e insatisfactoria de lo que no tienes, entonces yo, miro a mi alrededor y veo lo que hay dentro de mí para poder cumplir mis sueños y llegar a lo que puedo. Estamos empezando y creciendo; yo creo que usando lo que tengo dentro de mí para hacer lo mejor que pueda será siempre lo más valioso” aseguró Joaquina.
Sobre la visita a México, recordó que en septiembre pasado estuvo en las oficinas mexicanas de Universal, cantando para un evento privado que la hizo emocionarse mucho, aunque las de este momento son sensaciones distintas, pues Bajo Circuito representa su primer encuentro con el público mexa. “No es por nada pero ustedes son lo máximo, me emociona conectar con la gente de allá, es mucha efervescencia. Tanto calor, tanta pasión, estoy muy emocionada y conmovida por lo que va a suceder.” Joaquina concluyó reflexionando sobre la cotidianidad de su música, del poder que sus canciones tienen como una cámara para fotografiar su vida, como una libreta para hablar de las cosas en las que piensas, las que absorbe, las que están en el tintero siempre y son motivo de alegría o desilusión. Joaquina es una artista, sin duda, comprometida con la sinceridad de su espíritu.






Ambos estadounidenses salen favoritos este domingo para ganar el segundo Major de la temporada
Avelina Merino deportes@cronica.com.mx
El estadounidense Collin Morikawa alcanzó a su compatriota Xander Schauffele en el liderato del PGA Championship, segundo Major de la temporada, con un acumulado de -15 golpes después de 54 hoyos jugados. El sábado fue un desastrosa para Scottie Scheffler, núme-
ro uno del mundo, quien perdió muchas posibilidades de pelear por el título.
Morikawa, que inició su tercer recorrido en segundo sitio detrás de Schauffele, terminó la ronda en el Valhalla Golf Club de Louisville, Kentucky, con 67 golpes (-4), después de embocar 5 birdies y un bogey.
Fue así como pudo igualar en lo alto de la clasificación a Schauffele, que culminó la jornada con 68 golpes (-3).
El estadounidense que ha estado en la cima durante todo el torneo empezó con birdies en los hoyos 7, 10 y 12 pero perdió provisionalmente el liderato con un doble bogey en el hoyo 15.
Schauffele se recuperó con otros dos birdies en los hoyos
17 y 18 para quedar con un acumulado de -15 impactos. Ambos líderes son escoltados por el también estadounidense Sahith Theegala, que tras empezar la ronda con dos bogeys en los hoyos 5 y 6 se recuperó con 6 birdies para terminar con 67 golpes (-4) y un acumulado de -14, a un solo golpe de Morikawa y Schauffele. El irlandés Shane Lowry fue el mejor de la jornada, tras firmar 9 birdies. Lowry es ahora cuarto en la tabla con un acumulado de -13, empatado con el estadounidense Bryson DeChambeau, jugador LIV Golf y el noruego Viktor Hovland.
DERRUMBE DE SCHEFFLER
Scottie Scheffler pagó este sábado las consecuencias de su caótico día de encarcelamiento el viernes. Fue detenido al intentar saltarse un retén policial y ser transportado a la cárcel antes de quedar libre y regresar al campo de golf.
El número 1 del mundo jugó una notable ronda tras el incidente con 66 golpes (-5) que le valieron para acercarse al liderato, pero este sábado terminó con 73 golpes (+2), llevando su acumulado a un -7 y cayendo a la posición 24 de la tabla. Scheffler empezó la jornada con un doble bogey en el hoyo 2 y dos bogeys seguidos en el 3 y el 4. Luego lograría cinco birdies, pero otros tres bogeys lo terminarían poniendo dos sobre el par en la ronda.
LOS LATINOS
El chileno Joaquín Niemann subió a la posición 54, con un acumulado de -3, tras terminar la jornada con 69 golpes (-2), mientras que el argentino Alejandro Tosti cayó a la última posición con un acumulado de +3, después de una horrible ronda de 79 golpes (+8) con dos birdies, dos bogeys y cuatro dobles bogeys.
El esloveno Tadej Pogacar (UAE) no pudo esta vez superar la velocidad del especialista Filippo Ganna (INEOS), que se impuso este sábado en la etapa 14 del Giro de Italia, disputada en la modalidad de contrarreloj individual entre Castiglione delle Stiviere y Desenzano del Garda, con un recorrido de 31.2 kilómetros.
En una etapa casi en su totalidad en terreno llano, con un inicio con curvas antes de las rectas para los velocistas, Ganna tomó su ventaja tras el mal sabor de boca con el que se marchó en la séptima etapa, en la que Pogacar fue el único que le superó en el último suspiro, después de que estuviera media hora como líder en la silla caliente.
El andarín Ricardo Ortiz se sumó al equipo mexicano olímpico de caminata al registrar 1:18’31” en los 20 kilómetros de caminata durante en el Gran Premio Internacional de Cantones La Coruña, España, que se disputó este sábado.
De acuerdo con información de la Federación Mexicana de Asociaciones de Atletismo (FMAA), con ese registro el andarín veracruzano cumplió con la marca de 1:20’10”, establecida por la World Athletics como clasificatoria a los Juegos Olímpicos de París 2024.
Al mismo tiempo Ortiz supera la marca de su connacional Ever Palma (1:19’26”).
“Hay que recordar que aún no se cierra el proceso clasificatorio y no se deben descartar cambios hasta que culmine el calendario clasificatorio internacional reconocido por la World Athletics “, dijo Antonio
Lozano, titular de la FMAA, a través de un comunicado.
De esta manera Ricardo Ortiz se suma a José Luis Doctor y Noel Chama quienes también ratificaron su registro en la prueba, con 1: 19’14” y 1:19’21”, al ocupar las posiciones 11 y 14, respectivamente.
ALEGNA GANA PRESEA DE PLATA En la misma competencia, pero en los 20 kilómetros femenil, la también mexicana Alegna González terminó en segundo sitio con un registro de 1:26’57”, sólo detrás de la peruana y bicampeona mundial Kimberly García 1:26’41” y por delante de la china Hong Liu 1:27’11”.
Mientras Alejandra Ortega registró con 1:29’29” e Ilse Guerrero hizo 1:29’37”.
Antonio Lozano Pineda, comentó que las tres mexicanas ratificaron su plaza olímpica por ranking internacional.
(Avelina Merino)

Ortiz cumplió uno de sus sueños.
có su séptima victoria en el Giro, la primera desde 2021.
El italiano reventó el crono, que voló en su especialidad para pararlo en 35:02, siendo el único que se acercó a bajar de los 35 minutos con velocidades en algunos tramos de hasta 70 km por hora. Pogacar hizo casi medio minuto más pese a que durante los primeros controles marcó mejor tiempo que un Ganna que rubri-
El equipo INEOS terminó con tres corredores en el top-5, pues el neerlandés Thymen Arensman y el inglés Geraint Thomas hicieron el tercer y el cuarto mejor tiempo, a poco más de un minuto de su compañero de equipo, la gran estrella de la jornada.
Después de la exhibición del italiano, una dolorosa caída del estadounidense Magnus Sheffield, que había marcado el segundo mejor tiempo en el segundo paso cronometrado, sacó de concentración a los ciclistas.
Tadej Pogacar empezó con
mucha fuerza, el esloveno, ganó segundos en las curvas para marcar hasta 15 segundos menos que el crono de Ganna. Pareció que la historia volvería a repetirse y que Ganna se iba a quedar con la miel en los labios, pero poco a poco fue perdiendo fuerza el debutante en el Giro, máximo favorito.
Este domingo inicia el tríptico montañoso por los Alpes con la etapa reina: 222 kilómetros entre Manerba del Garda y Livigno, con cinco puertos en el recorrido, entre ellos el Mortirolo, Foscagno y Passo di Eira, donde estará la meta.
México estará presente con cuatro mexicanos en la Final de Copa del Mundo de Pentatlón Moderno (UIPM) que se celebrará en Ankara, Turquía del 22 al 26 de mayo.
A la Final Copa del Mundo de Pentatlón Moderno en Anka-
ra, sólo asistirán al evento los 36 mejores competidores de la actual temporada, tanto en la rama femenil como varonil, informó la Unión Internacional de Pentatlón Moderno (UIPM) en un boletín en la presente semana.
Los mexicanos que se gana-
ron el derecho de ser invitados a tan importante evento, considerado la antesala de los Juegos Olímpicos París 2024, son Catherine Oliver, Tamara Vega, Mariana Arceo y Emiliano Hernández, subcampeón mundial.
Desde la perspectiva de la UIPM, el Relevo Mixto de México promete ser cautivador tras haber ganado en la actual temporada de Copas del Mundo dos medallas de oro y de bronce.
Será la Federación Mexicana de Pentatlón Moderno

“Checo” Pérez sin más opción que remontar en Imola

El piloto mexicano largará undécimo, mientras Max Verstappen desde la pole position en el GP de Emilia Romagna
Avelina Merino deportes@cronica.com.mx
Max Verstappen saldrá desde la pole position para el Gran Premio de Emilia Romagna, mientras su compañero de Red Bull Sergio ‘Checo’ Pérez no ten-
drá más opción que remontar, pues saldrá desde la undécima posición al no pasar siquiera a la Q2.
Mientras el neerlandés sumó su séptima pole consecutiva, el mexicano tuvo un sábado complicado con su RB20 y saldrá desde el undécimo sitio.
CASTIGO A PIASTRI
Desde el sitio dos largará Lando Norris, que subió un lugar tras la sanción de la FIA a Oscar Piastri, quien fue enviado al quinto sitio. Charles Leclerc saldrá tercero y Carlos Sainz en cuarto lugar.
Por primera vez desde que arrancó la temporada 2024 de la Fórmula 1, ‘Checo’ Pérez no había tenido tantos problemas en las sesiones libres y en la clasificación.
El sábado desde la práctica libre 3 el mexicano tuvo un accidente que provocó que no pudiera mejorar su tiempo y terminó en el duodécimo sitio con tiempo de 1:15.706.
SALIDA DE LA PISTA
Ya en la calificación, una salida de la pista en la Q2 privó al ‘Checo’ de poder avanzar a la Q3.
Para Pérez todo cambió cuando le colocaron neumáticos nuevos, pues no esperaba tener mucho agarre en la parte trasera y, a su juicio, es fue clave para que se fuera recto en la curva 7 del circuito.
“En la Q2 colocamos gomas usadas en mi primer intento. Cuando coloqué el nuevo gané grip trasero en el coche y eso provocó que me fuera recto en la curva 7 porque gané más grip de lo pensado. Eso nos perjudicó” aseguró para Fox Sports.
FRUSTRACIÓN EN EL TAPATÍO
Tras lo anterior Pérez queda frustrado pues consideró que el Red Bull tenía todas las condiciones para quedar más arriba en la parrilla de salida.
“Pienso que teníamos más potencial y no lo demostramos. Fue una calificación en la que no logramos entrar en ritmo” dijo.
Más abajo que el tapatío se colocaron pilotos de nombre como Valtteri Bottas quedando fuera en Q1, Fernando Alonso otra gran sorpresa al ser 19, Logar Sargeant quien ni siquiera pudo competir por lo que saldrá de la última plaza.
El Gran Premio de Emilia-Romagna se correrá este domingo 19 de mayo en punto de las 7:00 pm (Centro de México)..
la que determine quienes integrarán en Relevo Mixto en Ankara.
“La final de la Copa del Mundo de Pentatlón UIPM 2024 promete ser una ocasión trascendental, ya que será como un ensayo general para los Juegos Olímpicos, con 36 atletas femeninos y 36 masculinos compitiendo en semifinales, y la mitad de ellos clasificándose para la final”, dijo el Dr. Klaus Schormann, presidente de la UIPM. (Avelina Merino)
Iga Swiatek gana por tercera
La polaca Iga Swiatek conquistó por tercera vez el WTA 1000 de Roma, tras imponerse con autoridad a la bielorrusa Aryna Sabalenka por parciales de 6-2 y 6-3. Iga llegará en todo lo alto a Roland Garros.
Swiatek, ganadora en las ediciones de 2021 y 2022, disipó cualquier duda sobre quién es la mejor tenista del circuito al volver a ganar a Sabalenka, número 2 del mundo, a la que también ganó recientemente en el torneo de Madrid.
En final con sabor a revancha, Swiatek volvió a alzar los brazos para celebrar un título. Con una superioridad aplastante, atropelló a Sabalenka para terminar el torneo sin haber cedido un solo set.
Lejos quedaron este sábado los 3 sets de Madrid y la batalla épica. La favorita, tras un primer set arrollador, supo gestionar en un segundo mucho más igualado para aumentar sus números con la bielorrusa, ahora 8-3 a su favor en la relación victorias-derrotas.
CUARTO TROFEO DE LA TEMPORADA
Tras ganar los títulos de Doha e Indian Wells también sin perder un solo set, así como el de Madrid en 3 sets, la número 1
del mundo conquistó su cuarto trofeo de la temporada.
Además de convirtió en la tercera tenista en la historia que gana tanto Madrid como Roma de manera consecutiva, igualando a la rusa Dinara Safina (2009) y la estadounidense Serena Williams (2013).
El primer set duró 36 minutos, síntoma del nivel estratosférico de la polaca, que quiso acabar con todo a las primeras de cambio. Rompió dos de los saques de la bielorrusa y rozó un tercero que le hubiera permitido encarrilar con premura la manga. En el segundo, Sabalenka intentó resistirse y sacó su mejor tenis. Golpeó con potencia desde el fondo y se sostuvo desde el saque para mandar al fondo a una Swiatek a la que no le quedó más remedio que defenderse. No obstante, Sabalenka que acabó frustrada ante el muro polaco. Ni las 5 bolas de ‹break› que tuvo para ponerse 2-0, ni las otras 2 que tuvo para ponerse 3-1 inquietaron a un Swiatek que resistió con bravura para acabar con cualquier esperanza de tercer set. Un ‹break› en el séptimo juego puso el 4-3 a su favor y decantó la victoria. Roma tiene nueva emperadora, Iga Swiatek. (Agencias)


Corea del Sur se mostró como una democracia emergente que buscaba unirse al movimiento olímpico. Pero Corea del Norte pidió un boicot en el que participaron países como Cuba, Nicaragua y Etiopía. Seúl 1988 marcó el fin de los Juegos Olímpicos bajo la Guerra Fría, un periodo de tensiones políticas y rivalidades globales
Homenaje al espíritu olímpico
Dr. Mario Antonio Ramírez Barajas
Miembro permanente del Comité Olímpico
Mexicano
ARMONÍA Y MODERNIDAD
El cartel de Seúl 1988 mostró su visión de “armonía y progreso” con los aros olímpicos y el corredor con la antorcha, que representaban la unión y la aspiración hacia un futuro mejor.
Seúl 1988 usó la tecnología para la repetición instantánea en gimnasia. Fue la última vez que vimos a la Unión Soviética y Alemania Oriental en los Juegos antes de que desaparecieran por cambios históricos.
EL LEGADO DE SOHNN KEE-CHUNG
La ceremonia de apertura fue un momento memorable, especialmente por el conmovedor relevo final realizado por Sohnn Kee-chung, el ganador de la maratón en 1936 que tuvo que competir

bajo el nombre japonés que le impuso la ocupación de Corea. Su participación simbolizó la fortaleza y la resistencia ante las dificultades históricas.
La ceremonia de apertura también tuvo un momento triste cuando algunas palomas de la paz, traídas para ser soltadas simbólicamente, murieron abrasadas por el fuego olímpico. Este incidente, aunque desgraciado, marcó la peculiaridad de estos juegos.
EL CONTEXTO POLÍTICO
Corea del Sur se mostró como una democracia emergente que buscaba unirse al movimiento olímpico. Pero Corea del Norte pidió un boicot en el que participaron países como Cuba, Nicaragua y Etiopía. Seúl 1988 marcó el fin de los Juegos Olímpicos bajo la Guerra Fría, un periodo de tensiones políticas y rivalidades globales que se reflejaron en esta competencia deportiva de prestigio.
MOMENTOS INOLVIDABLES
Los nadadores Matt Biondi y Kristin Ot-

Los JO de Seúl 1988 fueron del 17 de septiembre y el 2 de octubre de 1988
159 Países asistieron

52
8,391 Atletas participaron en 163 eventos 2,194
1,546 Medallas repartidas Países ganaron medallas Mujeres participaron
to dominaron los Juegos con siete y seis oros, respectivamente. Vladimir Artyomov en gimnasia, Florence Griffith-Joyner en atletismo, Steffi Graf en tenis y Greg Louganis en saltos de trampolín también fueron figuras destacadas, se recuerda el golpe en la cabeza de Louganis, quien a pesar de eso ganó el oro. El futbol lo ganó la Unión Soviética frente a Brasil y el tenis de mesa debutó como deporte olímpico. La descalificación de Ben Johnson por dopaje fue un escándalo que afectó al atletismo.
ESPÍRITU DE NOBLEZA Y HUMANIDAD
La medalla Pierre de Coubertin otorgada a Lawrence Lemieux, que sacrificó su posición en la vela para rescatar a un competidor herido, personifica el espíritu de nobleza y humanidad de los atletas olímpicos.



 El cartel oficial
El cartel oficial